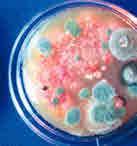

Til kamp mod algerne

SÅDAN FÅR DU HAS PÅ BÆSTERNE

MIDDAG MED

VITAMIN & VELSMAG


Nu er det tid til grøntsager








ideer til dig fra din nabo 7




● Soda-blæsning til snavs og lak
● Tips til maling inde









Ring på 98544311 og aftal nærmere















![]()












Til kamp mod algerne

SÅDAN FÅR DU HAS PÅ BÆSTERNE

MIDDAG MED

VITAMIN & VELSMAG


Nu er det tid til grøntsager








ideer til dig fra din nabo 7




● Soda-blæsning til snavs og lak
● Tips til maling inde









Ring på 98544311 og aftal nærmere









































og deres forældre







































BETINGELSER:
— Book på www.jesperhus.dk
— Opholdet skal koste min. 2000,-
— Indtast rabatkode 1805
— Gælder til og med 2. april 2018
Hvis ferien koster mindre end 2000 kr., giver vi 100 kr. i rabat. 7OO,i rabat på alle ferieophold
Tilbuddet er for 4 personer og gælder alle vores ferieophold
Der kan opnås ialt 700 kr. i rabat. Kan ikke kombineres med andre rabatter.




















Se næstepriserside



og deres forældre




BETINGELSER:
— Book på www.jesperhus.dk
— Opholdet skal koste min. 2000,-
— Indtast rabatkode 1805
— Gælder til og med 2. april 2018
Prisen er for 4 personer, 4 overnatninger (fredag-tirsdag)
• Fri entré til Hugos Badeland
• Fri entré til Parken inkl. forlystelser
• Slutrengøring
• Rabatten er fratrukket
Familetelt 1498,-
Totalpris for 4 pers.
C-hytte
2298,-
Totalpris for 4 pers.
Prisen er for 4 personer, 3 overnatninger (fredag-mandag i uge 25)
• Fri entré til Hugos Badeland
• Fri entré til Parken inkl. forlystelser
• Slutrengøring
• Rabatten er fratrukket
Familietelt
1398,-
Totalpris for 4 pers.
Hugos Legehytte
5298,-
Totalpris for 4 pers.
Hugos Legehytte
4798,-
Totalpris for 4 pers.
Feriehus
6798,-
Totalpris for 6 pers.
Prisen er for 4 personer, 2 overnatninger (mandag-onsdag i uge 28 eller 31)
• Fri entré til Hugos Badeland
• Fri entré til Parken inkl. forlystelser
• Kæmpe aktivitetsprogram
• Slutrengøring
• Rabatten er fratrukket
Egen campingvogn 1898,-
Totalpris for 4 pers.
Egen campingvogn kun 100,- rabat
Familietelt
2298,-
Totalpris for 4 pers.
A-hytte
3798,-
Totalpris for 4 pers.
Tilbuddet er for 4 personer (feriehus 6 personer) og gælder alle vores ferieophold. Ekstra personer (max. 2 ekstra personer), betaler 10% ekstra pr. person. Der kan opnås ialt 700 kr. i rabat. Kan ikke kombineres med andre rabatter.
Hvis ferien koster mindre end 2000 kr., giver vi 100 kr. i rabat.

































tilbage – vi kan se mod rigtigt forår og varme
Til kamp mod alger
Haven i marts
Nyt til Hus & Have
Læsernes ideer

Så meget vand bruger en gennemsnitsdansker HVER ENESTE DAG.
Tager du en familie med to voksne og to børn bruger den ca. 140 m3 om året t. Og med en pris på ca. 62 kr/m3, får familien en regning på vand, på ca. 8.680 kr.
Vandet bruges til:
Bad og personlig hygiejne 36%
Toiletskyl 27%
Tøjvask 13%
Opvask/rengøring 10%
Mad og drikke 7%
Øvrigt 7%
Kilde: DANVA





Skønt er det, når du bevæger dig udendørs – og pludselig kan mærke solen i ryggen. Det er NU, vi skal nyde alt det derude. I månedsvis får vi masser af lys og – forhåbentlig – også vejr, så haven kan bruges MAKS. Se, hvordan du kan fjerne algerne fra træværket allerede nu og vær med, når Lotte Bjarke giver tips om, hvordan du lokker foråret frem i haven. Og efter en dejlig dag derude, kan du rykke inden døre, tænde et par lys og servere en dejlig middag for fammilie eller venner. Vi giver dig et velsmagende forslag.
og velsmag
til grøntsagere
Redaktion
Chefredaktør og ansvarlig udgiver, Anna-Lise Aaen
Layout og tryk
Susanne Bruun, Art Director
Salgsdirektør
Tommy Sverre Willumsen
Salg
Finn Ryberg · Henrik Gerner
Qvottrup · Jimmy Rørbæk
Kristoffer Baagøe · Mikkel Saabye
Camilla Spies
Tryk Prinovis
DISTRIBUTION til alle villaer/ rækkehuse/gårde
ISSN 1903-184X idényt.vi i villa Oplag 1.032.473 (tilmeldt Dansk Oplagskontrol)
trykkesidénytpå
ØKOPAPIR
idenyt · Benjamin Media
Finsensvej 6D · 2000 Frederiksberg Tlf. 70 22 02 55· idenyt@idenyt.dk www.idenyt.dk

Pindstrups øko-serie giver dig alt, hvad du skal bruge for at dyrke dine egne økologiske grøntsager
Økologisk dyrkning bliver mere og mere populært, og derfor udvikler vi løbende vores øko-serie. Den rummer nu fem produkter, som dækker alle behov:
Med Så- og Priklemuld kan du dyrke dine grøntsagsplanter fra frø eller stiklinger. Senere kan de udplantes i den muld, der passer til netop dine planter. Krydderurtemuld giver friske og sunde krydderurter. Køkkenhave- og Jordforbedringsmuld er en all round-muld til de fleste typer grøntsager på friland, dvs. til køkkenhaven og i højbede. Og Plantesækken er særligt beregnet til at bruge i drivhuset og/eller sammen med Maxikap-selvvandingskassen.
Alle produkterne i øko-serien er udviklet, så de rummer netop det, dine planter har brug for. I de fire typer muld er der en økologisk startgødning til den første tid. Når dine planter senere skal gødes, kan du bruge den Flydende Gødning for at sikre et godt udbytte.
Pindstrups produkter forhandles af:
Havecentre, planteskoler, Plantorama, Bauhaus, Bilka, STARK, XL-Byg, Davidsen, Johannes Fog, 10-4 m.fl.
























Med Pindstrup Maxikap og
Plantesæk til økologisk dyrkning er det let at dyrke sine egne økologiske grøntsager – i drivhuset eller på terrassen.
Pindstrup har en serie af havetilbehør, som gør dyrkningen nemmere, og som hjælper dig til at få et godt udbytte af dine grøntsager.
Minikap
Et mini-drivhus med selvvanding, hvor du sår frø eller planter stiklinger i Så- og Priklemuld. En vandingsdug trækker vand op til mulden og planterne, og et plastlåg sikrer den rette fugtighed, så dine planter får en god start.

Grow Home Bucket
Et mini-drivhus, som giver mulighed for at dyrke på kun lidt plads, gerne i Køkkenhave- og Jordforbedringsmuld. Kan bruges til mange typer grøntsager og er særligt velegnet til knoldvækster som kartofler og jordskokker, som kan „plukkes“ fra den inderste spand uden at høste hele planten.


Jord er ikke bare jord
Maxikap har hele i
En kapillær-vandingskasse, som bruges sammen med Plantesækken. Plant dine grøntsagsplanter i mulden, som trækker vandet op til planterne. Med en fyldt beholder kan det hele passe sig selv i 1-2 uger.

Maxiflex
En dekorativ kasse til Maxikap og Plantesæk, som pynter på terrassen eller i drivhuset. Stil flere kasser ved siden af hinanden og brug dem som „rumdeler“, så du skaber forskellige rum på din terrasse.

Pindstrup udvikler og sælger voksemedier, der er baseret på sphagnum, både i Danmark og på eksportmarkederne. Vi har et tæt samarbejde med professionelle gartnere i hele verden, og det giver os en viden, som vi også bruger til at udvikle de bedste produkter til brug i private haver. www.pindstrup.dk/hobby
70.000 kr.


Med et tag fra Profilmontage sikrer du dig et smukt, dansk ståltag – tilpasset dine ønsker!
Profilmontage yder op til 40 års garanti, så du kan vælge den langtidssikre tagløsning. Vi tilbyder også den smukke, vejrbestandige og vedligeholdelsesfrie løsning, der afviser alger og mos med skjulte skruer og eksklusive vindskeder i zink. Hvis dit hjerte banke for miljøet, har vi også en løsning til dig. Det ”grønne” tag er udarbejdet i 100% genanvendelig materialer. Det leveres med solceller og regnvandstønde. Læs mere på voresgrønnetag.dk
Lad Profilmontage stå for monteringen af dit nye ståltag. Vores professionelle Profilmontage-håndværkere udfører hele arbejdet. Så er du sikret en komplet løsning. Vores brede produktprogram gør det muligt at finde den profil, der passer perfekt til dit hjem.
Se mere på profilmontage.dk

Tagstensplade, 10 års garanti
Tagstensplade, 40 års garanti
100% genanvendelige materialer
Ekstra lyddæmpede tagplader
Komplet aluzink tagrende m. nedløb “Skjulte” skruer
Vedligeholdesesfri vindskeder i stål
Eksklusive vindskeder i zink
Solceller, 4,76 kW anlæg
Regnvandstønde
Pris incl. moms fra kr.
Pris pr mdr. fra kr.
Kun 2,21% i årlig rente – op til 350.000 kr.
Ingen krav til sikkerhedsstillelse. *Lån fx. kr. 70.000,00
*Lånet tilbydes I samarbejde med Resurs Bank. I beregningerne er det forudsat, at et givent lån er optaget den 15. i en given måned.
måneder kr. 120,00
rente / Variabel 2,21%
Vi har god økonomi: Kun 0,19 % af boligejerne i DK har svært ved at betale deres termin
Ideen med at hamre en sten ned i en anden genstand var så enkel, at vores forfædres hjerner selv for 2,4 mio. år siden var udviklede nok til at gennemskue princippet.
Dermed er hammeren – i hvert fald hvis folk medtager den ydmyge prototype, sten i hånd – verdens ældste værktøj. Det tog dog en rum tid at udvikle hammeren, som vi kender den i dag.
Først for 30.000 år siden fik et menneske det lyse indfald at binde stenen til en læderrem for at få mere slagkraft. Og langt senere opfandt en anden kreativ håndværker den moderne hammer ved at montere slaghovedet direkte på et træskaft med snor eller læderstrimler.


99,9 % er gode betalere
Et nyt badeværelse, nye vinduer eller en pavillon i haven. Sådan ser Top3 ud blandt os villaejere, når vi skal beskrive, hvad vi ønsker os til vores hus her i 2018. Det fremgår af en undersøgelse som HUSET i Middelfart gennemførte i 2017 blandt deres godt 100.000 besøgende på udstillingen. Hele 41 % forventede at investere 50.000250.000 kr.på huset, mens 32 % forventede at skulle bruge over 250.000 kr.
– Vi oplever, at de besøgende er langt tættere på en beslutning om at købe et bestemt produkt, før de kommer her end tidligere," siger direktør Jan Røgind Jørgensen og fortsætter: "før i tiden kom folk for at få inspiration, mens de i dag ofte kommer for at se og røre produkterne samt få faglig rådgivning og detailinformation".
ET låg, der passer til alle gryder – og som samtidig reducerer muligheden for, at kartoflerne koger over. Det lyder lidt hokus pokus, men vi fik syn for sagen. OneLid hedder produktet. Et let, silikonebelagt låg, der passer til alle gryder op til 22 cm i diameter. Låget har et unikt rillesystem, der leder den rigtige mængde overskydende damp ud af gryden, så overkogning forhindres. Vi kogte kartofler og ris i to forskellige størrelser af gryder med samme gode resultat. Låget holder tæt. Du kan røre ved det uden at brænde dig, og det er nemt at hælde væske fra om nødigt. Anvendes til alle gryder op til en størrelse på Ø 22cm.
Bonus: Låget har et elegant design (så det kan gå med på middagsbordet). Det fås i flere farver – og i glas fra maj måned. Set til: ca. 300 kr.







Grønne alger og mos på taget. Øv.
Roof Cleaner fra Nilfisk lover "rent" tag i en slags tretrins-raket: En RoofCleaner, din højtryksrenser og en dunk algemiddel.



Renseren var nem at montere på højtryksrenseren og efter et par fejlskud, ramte vi præcis med algemidlet. Vi påførte midlet på et ca. 100 m2 tag på under to timer med oprydning. Så var det bare at vente.
I løbet af den næste måned visnede alger og mos – og forsvandt eller endte i "klumper" i tagrenden.
Gør det selv-løsning til rengøring af tag er set til ca. 500 kr. for Roof Cleaneren og ca. 100 kr. for 5 liter algemiddel. Tagrenseren passer til højtryksrensere fra Nilfisk
Hvad er mere praktisk end at brygge kaffen i den kande, den serveres i? Espro/Witt har udviklet Press P7 kaffekanden, der brygger velsmagende kaffe, som holder sig varm i timevis – og rengøringen er super nem. Kanden har mikrofiltre, der trækker ALT ud af bønnen og efterlader kaffen uden grums. Når stemplet trykkes ned, forsegles kaffegrumset. Vi skulle lige "samle" filter og trækpapir et par gange, så var metoden helt på plads.
Bonus: Elegant design, der passer ind i en moderne bolig. Kan også bruges til tebrygning
Materialer: Rustfrit stål (blank el. børstet).
Går i opvaskemaskinen. 2 størrelser
Set til priser fra 800 kr.


TRUSTPILOT


- med professionel fliserens og imprægnering
I ÅR HAR VI 10 ÅRS JUBILÆUM
DET FEJRER VI MED 20% RABAT





TILFREDSHEDSGARANTI
Gratis prøve inden opstart




INDTIL 1. MAJ
Fordi vi holder hvad vi lover, højt service niveau og kvalitet 15 ÅRS GARANTI*

*Nanostone fliserens og imprægnering er utrolig effektiv mod alger, flisepest og mos. Med vores mange års erfaring og service kan vi tilbyde op til 15 års holdbarhed.


Landsdækkende, ingen kørselstillæg Ring 42 36 66 66 alle ugens dage - hverdage 8-18, weekend 10-16
www.nanostone.dk info@nanostone.dk
















Gælder bro- og landfaste områder
Netskydedør
Forsatsdør
Netforsatsdør med sort glasfiber insektnet. Leveret efter mål til alle typer døre i hvid eller brun.
Pris kr. 1.875,-
ekskl. moms kr. 1.500,Uanset mål op til 100 x 234 cm

frokost er lige blevet 1.941.000 bakterier rigere!



Pris pr. netskydedør med sort glasfiber insektnet, inklusiv køreskinner. Leveret efter mål til alle typer døre i hvid eller brun.
Pris kr. 1.875,-
ekskl. moms kr. 1.500,Uanset mål op til 122 x 240 cm


Insektnet rullenet fungerer som et rullegardin. Passer til alle typer vinduer og boligtyper. Leveres i bredde fra 43cm til 153cm. 45 størrelser med 2,5 cm interval. Højde 150cm.
Pris fra kr. 750,-
ekskl. moms kr. 600,-












Her ser du hvordan den rengjorte, algefrie og olierede terrasse skal se ud. Det er jo et pragtsyn!



Algerne har det rigtigt godt i det fugtige klima
Algebelægninger er grønne, slimede og grimme og gør terrassen glat. De holder på fugten, så træet nemmere rådner. Sådan fjerner du dem!
Algerne har det superfint med klimaændringerne:
fugtigt forår, lange perioder med regn om sommeren, fugtigt efterår og så en vinter uden rigtig frost.
Det får de slimede algebelægninger til nærmest at strutte af grøn glæde. Særligt på skyggefulde steder breder de sig på hegn, tag, terrasser, havemøbler osv.
Og vi kan lige så godt sige det: Du kan ikke komme dem til livs sådan for alvor. De

At fjerne alger klares ikke på et par timer. Først skal algerne behandles med algemiddel. Midlet skal virke over tid, og så skal der skrubbes.
"bor’"alle vegne, drysser ned fra store træer, kommer ned med vandet fra taget og blæser med vinden lige ind på din terrasse.
Vil du tage kampen op mod algerne og vinde – for et stykke tid – kræver det algerens, husvask, en stiv børste og en god portion knofedt. Knofedtet kan udskiftes med en teenager, der har brug for lommepenge eller en gulvslibemaskine. Det ven-
der vi tilbage til. Start med at skaffe og indkøbe de redskaber og væsker, du har brug for. For det første skal du have et middel, der dræber algerne. Sørg for, at det er godkendt til formålet – det ender jo ude i din have og i miljøet.
Herudover skal du bruge en stiv kost/børste, en havesprøjte, husvask og vandslange. Så er du bevæbnet og kan gå til angreb. Tekst og fotos: Lise Mortensen, Ecostyle.dk og wocadenmark.com

MOPPEN
Du kan også anvende en gulvmoppe, når du skal oliere terrassen.

DEN GODE HJÆLPER
Hvis du har en stor terrasse, kan det betale sig at leje en gulvslibemaskine i byggemarkedet og montere den med en børste. Det gør underværker på terrassen.
Forbered træet
Start med at feje terrassen for skidt, snavs og blade, så der er adgang til træet. Herefter skal terrassen sprøjtes med algemiddel – se blandingsforhold på emballagen.
HUSK! Alger dør kun én gang. De dør ikke mere af, at du overdoserer!
Det er vigtigt, at træet er fugtigt, når du sprøjter det over. Det skal helst foregå i fugtigt vejr – dog ikke regn. Faktisk skal der helst være tørvejr i minimum seks timer efter, du har sprøjtet.
Nu lader du algemidlet sidde et døgns tid og gerne længere, til algerne har skiftet farve fra grøn til brunlig. Det er tegn på, at de er døde.
Næste skridt er det hårde
Nu skal terrassen skrubbes ren for alle belægninger, skidt, snavs og gammel stivnet olie mv. Det kan gøres på flere må-
der: med en gulvskrubbe eller en anden stiv børste og masser af knofedt. Er det hårdt? – så glæd dig over, at du får motion.
En anden løsning er at leje en gulvslibemaskine i et byggemarked – og montere en børste af silicium. Det er meget effektivt og renser træet helt i bund.
Endelig kan husets teenager formentlig lokkes (eller købes) til at skrubbe.
Når hele terrassen er skrubbet og spulet, skal den vaskes grundigt med trærens, til den fremstår helt ren.
Når terrassen er tør igen efter behandlingen, skal den have olie. Her er det vigtigt, at terrassebrædderne når at tørre helt, inden du giver dem olie. Hvis de ikke er helt tørre, vil vandet i træet forhindre olien i at trænge ned.
Det er også vigtigt, at træet er helt rent og uden belægninger – ellers lægger olien sig bare oven på algelaget og gør ingen nytte. Desuden vil den nye olie næsten uundgåeligt skalle
af, og terrassen skal meget hurtigt behandles igen. Så det duer ikke.
Og så er der vejret. Varmt og solrigt vejr er ikke nødvendigvis det bedste vejr, når træterrassen skal olieres. Som oftest vender terrasser mod syd, og i solskinsvejr kan træet blive så varmt, at olien hærder alt for hurtigt og slet ikke trænger dybt nok ned i træet. I stedet lægger olien sig som en skorpe eller hinde på overfladen og skaller hurtigt af.
En god terrasseolie styrker træet indefra og skaber en meget slidstærk og vandafvisende overflade, der minimerer træets opsugning af vand og dermed forebygger råd og svamp.
Når olien har siddet på et par uger, kan du evt. behandle træet med et imprægneringsmiddel. Det forhindrer ikke algerne i at komme igen – men det lægger sig som en teflonoverflade, der betyder, at rengøringen er meget lettere.
Træet skal være rent. "Rent træ" vil sige, at alle former for tilsmudsning, alger og mos er fjernet fra træets overflade.
Træet skal være tørt. Med "tørt træ" menes mere præcist, at fugtigheden i træet ikke overstiger 15%. Det betyder blandt andet, at arbejdet skal udføres i tørvejr og helst lidt op på formiddagen, så nattens dug er fordampet, og olien samtidig har hele dagen til at tørre, inden duggen atter falder.
Træet skal have den rette temperatur. Rent vejrmæssigt skal temperaturen helst ligge mellem 15 og 20°, så hærdningsprocessen kan forløbe i det rigtige tempo, og så olien kan nå at trænge dybt ned i træet.
Olien skal være god. Vælg en kvalitets-olie med indbygget UV-filter. Det beskytter træet mod solens ultraviolette stråler og modvirker solens blegende effekt.


Stonetreatment afrenser og imprægne- rer din flisebelægningPROFESSIONELT for 120 kr. pr. m2 Ring 43 75 25 65


Ved nye og rene belægninger kan Aktiv Fliseog betonimprægnering påføres direkte uden at afrense først med spray eller malerrulle.




Ved ældre belægninger, hvor overfladen er angrebet af mos og alger, afrenses fliserne med Stonetreatment Grundrengøring. Når fliserne er rene og tørre påføres Stonetreatment Aktiv flise- og betonimprægnering med spray eller malerrulle.
Har du fliser udenfor, så kender du udmærket problemet: Mos og alger sætter sig fast på fliserne, så de får grå, grønne og gullige skjolder. Men nu er det slut med grimme fliser.
Det er ikke kønt at se på, og hvis du ikke hvert eneste år smøger ærmerne op og fjerner mos og alger med grundig rengøring og algegift, bliver fliserne bare grimmere med tiden. Samtidig ødelægger den grove rengøring ofte flisernes overflade, så algerne bare sætter sig endnu bedre fast næste år. Med andre ord: Det er faktisk lidt af et kedeligt Sisyfos-arbejde.
Én behandling giver rene fliser i mange år frem Heldigvis kan du denne sommer sige farvel til både grimme fliser og kedeligt rensearbejde. For med et nyt, naturligt middel kan du både fjerne
1
Algebelægning
Luftens NOx-forurening sætter sig på flisebelægninger og danner grobund for alger og mos.
mos, alger og andet organisk snavs på fliserne og samtidig sikre, at det ikke vender tilbage. Faktisk kan du forvente, at flisebehandlingen er aktiv i op til 15 år, og det bedste er, at det hverken er besværligt eller giftigt.
”Aktiv flise- og betonimprægnering” er et naturligt vandbaseret produkt, hvor det aktive stof er mineralet titaniumoxid. Når titaniumoxid udsættes for lys, begynder det aktivt at nedbryde alger og andet organisk snavs på fliserne, samt hindrer det i at vokse. Titaniumoxid binder sig kemisk til

betonen og er aktivt i årevis - derfor kræver fliserne kun én behandling.
Miljøforbedrende initiativ til haven Titaniumoxid har desuden den ekstra funktion, at den kan rense luften i dine omgivelser. Den proces, der sættes i gang, når titaniumdioxid udsættes for lys, minder om træernes fotosyntese, hvor CO2 omdannes til ren ilt. Tilsvarende bruger titaniumoxid sollyset til at nedbryde luftens NOx-forurening, som kommer fra fx industri og biludstødning. Den nedbrudte NOx skylles væk af regnen.
”Aktiv flise- og betonimprægnering” forhandles i bl.a. Bauhaus, Johannes Fog og på www.stonetreatment.dk Pris fra 299,00 kr. pr. liter.

2
Nedbrydelse
Ved behandling med ”Aktiv flise- og betonimprægnering” nedbrydes NOx-forurening af sollyset.



3


Behandler du 100 m2 fliser, renser det luften i dine omgivelser svarende til, hvis du havde seks fuldvoksne træer i haven.
Ingen gift og ingen farveforskel Produktet består af vand iblandet det naturlige mineral titaniumoxid. Der findes bl.a. i de norske fjelde. Behandlingen giver ingen farveforskel.
Naturlig rensning
Regnen skyller den nedbrudte NOx-forurening væk sammen med alger og mos. Fliserne er rene i op til 15 år.







Selv mindre revner i taget eller små utætheder kan udvikle sig til dyre reparationer pga. følgeskader som råd og svamp, hvis de ikke udbedres i tide. De kan dog være rigtig svære at spotte for den almindelige husejer.
De skjulte skader
Et tilsyneladende sundt tag kan have små skjulte skader, der kan føre til dyre reparationer eller følgeskader. Det kan være utætheder i inddækninger, små revner eller tagsten

der ikke sidder helt, som de skal. Disse skader kan være svære at se for det
utrænede øje og rigtig kritiske, hvis de ikke opdages før, følgeskaderne sætter deres spor. Derfor anbefaler vi et tagtjek udført af en af vores kompetente konsulenter.
Renovering og reparation
Vi oplever ofte, at husejere kan nøjes med at få udskiftet de knækkede tagsten eller -plader, få tætnet taget eller udskiftet dele af træværket.
Udskyd tagudskiftning i 10 år

Bestil tid online
Vi har gjort det nemt at bestille tid online, når det passer dig.

Har du et ældre eternittag, der er falmet, men ellers er i god stand, kan du med fordel få det

renset og malet. En tagrensning og -maling kan udskyde en dyr udskiftning af taget i op til 10-15 år, og du får et tag, der fremstår som nyt. Dette vurderer vi selvfølgelig ved et tagtjek, så du får den bedste løsning.
Det får du med et tagtjek
Når konsulenten har gennemgået dit tag, træværk, inddækninger og tagrender, får du en detaljeret rapport, så du har overblik over tilstanden på de enkelte dele. Du får også forslag til udbedringer, tilbud på forbedringer og tips til vedligehold.
år imod
ca. 100 tons nedbør i form af regn og sne. Er dit tag klar til et år mere?

Kilde: Bolius






Bestil tid online
Vi har gjort det nemt for dig at bestille den tid og dato, der passer dig bedst. Bestil på www.bestil-dit-tagtjek.dk
Få en detaljeret rapport
Efter tagtjekket får du en rapport med vedligeholdelsestips, forslag til energibesparelser og eventuelle reparationer.














Små skader kan blive rigtig dyre, hvis de får lov til at udvikle sig. Tag dem i opløbet og hold udgifter og skader nede.












Ligesom de fleste bilejere...

får serviceret bilen, er det en god idé også at få efterset taget. Selv mindre revner i taget eller utætheder kan nemlig udvikle sig til dyre reparationer og følgeskader, hvis de ikke udbedres i tide.
Er dit tag mere end 40 år gammelt anbefaler vi, at du får et tagtjek og en status på dit tags tilstand.


Du får tjekket
Tagplader

75%


Tagrender
Tagrygning

Træværk

af de tage, Jydsk Tagteknik tjekker, har synlige eller usynlige skader – især ældre tage fra før 1980.

Inddækninger






Find prisen på dit nye tag her: www.jydsktagteknik.dk/ beregn






Grønne tips · Giv roserne gødning · forspir dahlia · riv mos væk · forspir læggekartofler · beskær træer

Påskeklokke, der hedder Helleborus x orientalis på latin, har status som årets første staude. Midt i marts står den i fuldt flor med hvide, limegrønne, støvet rosa eller næsten sorte blomster, der kan have de mest fantastiske farvetegninger. Planterne krydser sig nemt med hinanden, og det giver den store variation.
Påskeklokke er en super helårsplante at have i haven. Dels på grund af den tidlige blomstring, der varer meget længe. Dels fordi også frøstandene er smukke, og endelig fordi de mørkegrønne, læderagtige blade er vintergrønne og fungerer godt som bunddække, indtil de skal klippes ned medio februar for at give plads til de nye blomster og friske blade.
Påskeklokke er en nem staude Plant den i veldrænet, god muldjord –ikke i direkte sol. Planten stammer fra bjergegne i Sydeuropa, hvor den vokser i skovlysninger. Det er godt at vide, når man vælger plantested.
Primula Hornviol
Bellis
Vibeæg
Hyacint
Viol Iris Vibeæg
Kobjælde
Pletter i luften
Sølvtråd
Balkananemone


Når havens dæmpede farveskala ikke står helt mål med de behov, forårsfornemmelserne skaber, er der hjælp at hente blandt de tidligste forårsblomster, der egner sig til krukker, selv om temperaturen endnu er lav. Det gør en utrolig forskel at sætte en krukke med farvestrålende forårsblomster i et lunt hjørne og at pynte havebordet med planter. Så er det forår som ved et trylleslag.
Forårsblomsterne kan plantes tæt sammen i fine farvekombinationer i store krukker, eller de kan plantes i hver deres krukke og sættes i hyggelige grupper. Selv små potter på en bakke som forårsbordpynt er en mulighed, for netop fordi det endnu er køligt, er planternes vandforbrug behersket, så de er til at styre.
En hjælp til bierne
Men du glæder ikke kun dig selv og dine forårsfornemmelser ved at sætte lidt tidlig kulør på haven. De første bier og slidte, overvintrede sommerfugle, kan gå helt amok i sådan nogle krukker på en årstid, hvor naturen og haven i øvrigt ikke har meget nektar at byde på.
Krukker i krogene
De tidligste forårsblomster kan tåle temperaturer ned til omkring frysepunktet, men det er smart at placere forårskrukkerne de steder, hvor de er mindst udsat for frost. En lun krog med læ på terrassen er oplagt, og helt generelt kan du regne med, at der er varmest tæt ved huset og under et bredt udhæng. Trækker det op til frostklare nætter er det en god idé at give krukkerne en dyne af for eksempel fiberdug til lige at tage brodden af frostvejret.
Det giver forårsstemningen endnu et nøk at klippe de visne staudetoppe ned.
Frisk purløg er forårsvitaminer af højeste karat. De kan plukkes så snart de er nogle cm lange.
Klip toppen af forspirede ærteblomster. Så forgrener de sig, og det betyder flere blomster.


2 1 3 Trylforåret































Loungesæt model Coin kun 5.995,-
Fås også med hvide hynder. Loungesæt i pulverlakeret aluminiumsstel, flettet med sort 4 liner polyrattan i kraftig kvalitet. Består af 3-pers sofa med indbygget hyndebox, 2 stole og sofabord med 5 mm hærdet glasplade. Kraftige hynder 9 cm, samt rygpuder med sort polyester. Vandafvisende vaskbart betræk. Sofa str. L: 186 x D. 80 x H: 70 cm. Stole str.: B: 85 x D: 80 x H: 70 cm. Bord str. 100 x 60 x 44 cm. Siddehøjde: 45 cm. Der kan tilkøbes regncover.



5.000 SPAR 8.000, -


SPAR 2.700

Vitrineska bene er delvist

håndlavede. Derfor kan variationer i farve, finish og størrelse forekomme. Dette er IKKE fejl i produktet men en del af vitrineskabenes unikke look.

Sort vitrineskab kun 6.295,-
Sort helmalet vitrineskab i bemalet
træ. Indvendigt hvidmalet. Front med to glasdøre med 5 hylder bag. Profilering øverst samt rundt ved sideruderne. Beslag/greb af metal. Mål: H: 212 cm. B: 120 cm. D: 44/38 cm. Vægt 75 kg. Flere str. og farver.

3.200, -


kun 5.995,-
kun
Model Palencia Black. Mixed, sort polyrattan i kraftig kvalitet. Sorte, kraftige vandafvisende hynder på 10 cm, samt gode rygpuder. Sættet består af 6 moduler + sofabord med 5 mm hærdet glasplade. Siddehøjde 35 cm + 10 cm hynde - i alt 45 cm. God siddekomfort ved spisning. Kan opstilles på flere måder. Mål, hjørner: 86 x 86 x H: 84 cm (3 stk.) Mål, stole: 68 x 86 x H: 84 cm. (3 stk.) Mål, bord: 150 x 90 x H: 65 cm. Fås også i grå.
Skænk kun 4.495,-


Udført i hvidmalet træ. Profileret top. Greb af patineret messing. 5 skuffer samt 4 låger med hylder bag. H: 87 cm. B: 207 cm. D: 50 cm. Kommer samlet i en colli.



SPAR 4.500,

SPAR 3.000, -


Hvidt vitrineskab kun 6.795,-

Helmalet 2-delt vitrineskab, overdel med profileret top, front med tre låger m/glas og hylder. Underdel med skuffer samt låger med fyldninger. Indvendigt hvidmalet. H:197 x B: 160 x D: 43 cm. Kommer samlet i 2 Colli. Samlet vægt 99 kg.
• Masser af brugskunst i showroomet med 50% rabat.
• Vi har et kæmpe udvalg af lækre møbler i masser af lækre farver
• Se dem på direkteimport.dk
4.495,kun 2.495,-



Havemøbelsæt med 6 stole kun 2.495,-
2 m. Artwoodbord med antrazit, brush, artwoodlameller og pulverlakeret aluminiumsstel. 6 stk. Mijas polyrattanstole som kan stables, flettet med sort 4 liner polyrattan. Der kan være enkelte ridser på bordene,derfor nedsat pris. Mål Bord: L: 200 x B: 90 x H: 75 cm. Hynder medfølger ikke.
Vores kunder giver os 5 stjerner på Trustpilot
• FRI FRAGT
• Kæmpe udvalg
• Høj kvalitet
• Egen import
• Ingen dyre mellemled
• Du kan ringe til os










SPAR700, -




4 meter markise i hellukket sort aluminiumskasse med motor samt 2 stk fjernbetjeninger. 3 meter udfald. 2 arme. Monteret med kraftig overfladebehandlet vandafvisende grå polyesterdug på 300 gram/m2. Dansk brugervejledning medfølger. Tilbud så længe lager haves. Prisen er incl FRAGT til kantstenen. (Se fragtbetingelser på direkteimport.dk) Fås i flere længder og farver.

5.094, -


Hvidt, helmalet. Front med to glaslåger, glas i siderne og tre hylder. Indvendige mål: H: 121 cm. B: 81 cm. D: 26 cm. Kommer samlet - 1 colli. Indvendig hylde dybde 21,5 cm. Se billede med alle mål på direkteimport.dk


2,1 m Artwoodbord med sorte artwood lameller og antracitgrå pulverlakeret aluminiumsstel. 6 sorte Madrid justerbare polyrattanstole, flettet med sort, kraftig, 4 liner polyrattan. Mål: Bord: L: 210 x B: 90 x H: 75 cm. Der kan være småridser på bordstelderfor nedsat pris. Mål på Madrid stol: H: 110 x B: 61 x D: 59 cm. Siddehøjde på stole 42 cm uden hynde. Sættet er excl.hynderHynder kan købes løse i valgfrie farver og modeller.





kun 1.999,-








Hjørneloungesæt 6 moduler. Flere opstillingsmuligheder. Består af 1 hjørnemodul, 2 moduler m. ryg samt 3 stk. puf/bord. Håndflettet med 4 liner sort polyrattan. Kraftige, vandafvisende sidde- og ryghynder. Alle hynder har vandafvisende, sort, vaskbart, aftageligt betræk. Til sofabordet medfølger også hynde - så opstillingen kan laves om til en seng. Hjørnemodul str: 76 x 76 x 75 cm, 2 stk. rygmodul 76 x 66 x 73 cm, løst modul 76 x 76 x 34, løst modul 76 x 66 x 34 cm, sofabord 66 x 66 x 34 cm. Siddehøjde 44 cm. 5 mm hærdet bordplade samt 6 pyntepuder medfølger. Løse ekstra moduler kan også tilkøbes - eller Regncover. Modellen fås også med hvide hynder.





Fås også med lys. Længde: 300 cm. Bredde: 300 cm. Højde: 262 cm. Sort 200 g. polyesterdug. Antracitgrå, pulverlakeret aluminiumsstok med 360 graders drejefunktion. Parasolfliser kan tilkøbes, medfølger ikke.SPAR 5.000, -
Havemøbler bestående af rundt ø: 150 cm bordplade i Artwood, stel af pulverlakeret hvidt aluminium. H: 74 cm. Samt seks stabelstole med stel af pulverlakeret hvidt aluminium. Ergonomisk sæde og ryg af artwood. H: 93 cm. B: 56 cm. Farve: Modehvid. Design registreret i EU. God siddekomfort.Vores Artwood falmer ikke. Der kan tilkøbes hynder der passer til stolen i cremehvid, grå eller sort polyester. Fås i 3 str. og farver














Nærmeste forhandler findes bagerst i magasinet


1. Rosti Mepal Cirqula fås i nordic- blue, white, blush, green, lime og nordic black til priser fra 50 kr. Skålen kan bruges i fryseren, mikroovnen, og den kan maskinopvaskes. 2. Allux/Juliana står bag Bjørn postkassen. Den måler: H 525 x B 345 x D 235 mm. Fås i helt sort eller sort med aluminiumsfarvet front. Pris ca. 1.900 kr. 3. Sicily er en loftlampe med tre pendler. Egner sig godt over spisebordet eller sofagruppen. Detaljer i krom og armatur i glas. Set til ca. 2.140 kr. hos markslöjd.com 4. GastroMax/Orthexgro har designet den drypfri målekande. Med en tydelig mærkning, Tåler opvaskemaskine. Stabelbar med øvrige målekander i serien for effektiv opbevaring. 0,3 l. Til ca. 30 kr. 5. Staubtekande i støbejern inkl. teæg ca. 1.350 kr. 6. Højtryksrenser RE 88 fra Stihl vejer lidt og har gode kræfter. 7. Clothes Rack fra MALLING LIVING er perfekt til entreen, soveværelset eller kontoret. Set til ca. 1.500 kr. 8. Normies finurlige dekorationsfigurer –fra 5 til 10 cm. I beton og til priser fra ca. 100 kr. 9. Tom Dixon - Wingback Micro Sofa set til ca. 37.500 kr.




















Påskeægget er en århundreder gammel tradition i Danmark. Det er dog først i slutningen af 1800-tallet, at æggene bliver af slik og chokolade. Indtil da blev ægget særligt forbundet med påske, fordi det var i den samme periode, at hønsene be-
gyndte at lægge æg igen efter vinteren.
Det var vild luksus igen at sætte tænderne i et frisk hønseæg efter må neder, hvor man levede af det forråd, der var gemt fra sidste år.
Og sent på foråret var der sjældent meget tilbage af det.
At pynte op – ude og inde – behøver ikke at koste en bondegård. Til gengæld bliver de fleste glade, når hjemmet afspejler den kommende højtid PÅSKE.

DET GIVER EN fantastisk virkning at samle de gule indslag i små tableauer – frem for at sprede dem over hele boligen.


Gul er en af de lyseste farver, som øjet kan se. Goethe sagde, at gul fører lysets kvalitet med sig. Gul reflekterer faktisk mest lys af farverne i farvespektret, som er regnbuens farver. Derfor lyser selv de små undseelige erantis op i landskabet og fortæller, at nu er foråret her. Det er desuden undersøgt videnskabeligt, at de fleste bliver glade af den gule farve.
Mal selv dine æg
Når du vil dekorere æg ved hjælp af kogning, skal du være opmærksom på, at hvide æg giver de flotteste farver, mens brune og grå æg i sagens natur
giver mere mørke farver. En gul farve kan kun blive klar gul på hvide æg.
SÆT GERNE
dine gule blomster i en glasvase, så du kan se rodnettet. Det "smager" af forår.
Jeg vil male dagen gul, solen som en sommerfugl, sætter sig på mine hænder, alle regnvejrsdage ender... Pia Raug/E. M. Pedersen 1978
Det letteste er selvfølgelig at købe æggene udpustede og rengjorte. Men her skal du tage dig i agt. Der findes nemlig forskellige ægtyper i handelen, vistnok importerede og til billige penge.
Men ofte er de imprægnerede, sikkert for at dræbe bakterier, og langt de fleste imprægneringsmidler har desværre også den virkning, at farverne
ikke vil "bide" på æggene. Derfor er det bedre at ofre lidt mere og købe æg, du ved ikke er imprægnerede eller for den sags skyld renset i klorin, idet visse farver bliver forkerte, hvis der er klorin med i spillet. Gurkemeje giver en stærk gul farve, bruger du knust gurkemeje aftegner farven sig i felter, mens den er mere blandet med de øvrige farver, når du anvender stødt gurkemeje. Når du koger æggene med farveelementer, skal du vælge

Gule sommerfugle hører til de mere sjældne – og kalenderen skal sige maj, før du ser dem!
em mindre gryde og sørge for at æggene er under vand (brug låg med noget tungt ovenpå).
Æggene bringes langsomt i kog og skal koge i fra en til tre timer, alt efter hvor kraftige farverne skal være. Tag et æg op undervejs og se om farven er tilfredsstillende, hvis ikke, koges videre.
Du kan prøve at tilsætte alun, en slags salt, som skulle gøre ægget mere modtagelig for farverne, og dels for at reducere kogetiden.

Ude kan du hjælpe foråret på vej ved at samle krukker med forårsblomster på et sted.
Når æggene er tørre, skal de efterbehandles med olie eller lak. Bruges olie (alle former kan bruges), skal du nok gentage behandlingen et par gange, alt efter hvilke æg du bruger.Gnid efter med en blød klud. Skal æggene ligge i meget lys, er en efterbehandling med lak at foretrække, idet lakken gør dem mere lysægte. Her kan anvendes shellak, lak på dåse eller lignende.
Kilder, tekst og fotos: Tempa.dk, A. Aaen, Ibulb, Flickr mfl.
6
1
Hvorfor blev førertrøjen i Tour de France gul i 1919?
Gul er den farve, der ses bedst gennem tåge. Hovedsponeren, avisen L’Auto (nu L’Equipe), trykte på gult avispapir.
Gult er så flot.
2
I hvilket land fandt den såkaldt gule revolution sted i 1986?
3 Safran stammer fra planten safrankrokus. Hvilken farve har blomstens blade?
Gul e Røde Lilla
4
Hvornår lærte vi første gang Bamse at kende – tivertifald?
1982 1972 1992
5
To af de fem mest befolkede lande i verden har farven gul i deres flag. Hvilke?
6
Hvilket erhverv har Peter Pedals ven og fangevogter Manden med den gule hat?

En sjov kande fra et loppemarked er spraymalet og fyldt med påskeliljer – så får du solskin!





















Ønsker du at nyde en ferie, der fokuserer på nærhed, lækker lokalproduceret mad, aktiviteter i naturen og kunst- og kulturoplevelser? Så er Bornholm stedet for dig. Her finder du mere end 140 km kystlinje med fabelagtige hvide sandstrande, unikke klippeformationer og hyggelige gamle købstæder. Bornholms størrelse gør, at det aldrig tager mere end en halv time, at nå frem til den næste hyggelige oplevelse - uanset hvor du bor på Bornholm.
Sydbornholm direkte ved havet

2 pers. på Strandhotel

Dobbeltværelse, morgenbuffet, aftenmenu (3-retter eller buffet, afhængig af ugedag) og færge Ystad – Rønne t/r.
Pris for 3 nætter pr. pers. ved 2 pers.
Pris for 5 nætter pr. pers. ved 2 pers.
kr. 2.250,-
kr. 3.350,-
Gælder i perioden 26/4 til 12/6 2018. Alle værelser har tekøkken og balkon eller terrasse. Opvarmet udendørs swimmingpool. Gratis Sauna, parkering og WiFi.

Vestre Strandvej 25 • 3730 Nexø Tlf.: 56 49 22 25 mail@hotel-balkasoebad.dk
www.hotel-balkasoebad.dk
Historien har sat tydelige spor på Bornholm. Oplev f.eks. de smukke, gamle rundkirker eller Nordeuropas største borgruin, Hammershus, hvor et helt nyt imponerende besøgscenter er åbnet i år. Godt en times sej lads fra Gudhjem kan du besøge Christiansø, hvor det velholdte fæstningsværk vidner om øens fortid som flådebase.






le redningsstier, som går øen rundt.
Er du til aktiv ferie, så prøv de gode cykelstier, som strækker sig 230 km gennem øens varie-

Det bornholmske spisekammer er en oplevelse i sig selv. Rundt om på øen finder du mange små, hyggelige gårdbutikker med lokalt producerede fødevarer af høj kvalitet, som kokke fra hele
FOR- og EFTERÅRSTILBUD
Ferie med havudsigt i skønne omgivelser tæt ved Gudhjem
boliger til udlejning
Vi er klar til at hjælpe jer med at finde det helt rigtige sommerhus til ferien.

SKØN BJÆLKEHYTTE
3-4 pers. hytte m. toilet og havudsigt
STOR BJÆLKEHYTTE
4 pers. hytte m. bad, toilet og havudsigt
NY LUKSUSHYTTE











4 pers. hytte m. komfort som i et sommerhus










feriepartner.dk/bornholm Tlf: 5697 1220 bornholm@feriepartner.dk

Dette får I med: • 2 personer i 1 uge i skøn feriehytte • Færgen Ystad - Rønne t/r med bil
Sannes Familiecamping og Feriepark
Tlf.: 56 48 52 11 • sannes@familiecamping.dk
Se flere tilbud på www.familiecamping.dk







landet besøger øen for at få fat i. Prøv f.eks. øllet fra et lokalt bryggeri, nyrøgede sild på klipperne, håndlavede chokolader og is eller lækker bornholmsk tapas.
Du kan også opleve spændende kunstudstillinger, intime koncerter med kendte kunstnere, politikfestivalen ”Folkemødet”, jazz-festivaler, Kulturugen i september og m.m.

Det er nemt og hurtigt at komme til Bornholm. Du kan sejle fra Ystad i Sverige – kun 90 km fra København. Sejlturen tager lidt over en time – og færgebilletterne er nu endnu billigere.
Læs mere på bornholm.info


• Flot ferielejlighed på Dueodde
• Færge Ystad-Rønne tur/retur med bil
• Rengøring og strømforbrug
• Gratis guideture
• Totalt for 2 personer i 4 nætter: 2.995,Ankomst er mulig på alle ugedage
• Tillæg ved ankomst i perioden 9/6 -20/8

SENIOR-TOUR: TUREN GÅR TIL GUDHJEM

Oplev den rare, varme stemning af hygge og idyl, som Gudhjem er kendt for. Tæt på havet. Østersøens perle.
• 4 nætter i ferielejlighed
• Fiskebuffet på røgeri
• Entré til Oluf Høst Museet i Gudhjem
• Færge Ystad-Rønne t/r i egen bil


Der tages forbehold for trykfejl samt udsolgte varer.

Ens priser for bomulds- og mørklægningsgardiner
Transparent med tynde striber.
Leveres i farverne: Råhvid, beige, grå eller sort, med kædetræk.
Gælder til 9. april 2018
Vores speciale er trendy gardiner i enkelt design, som understreger boligens nuværende indretning og som formår at glide ind i hjemmet som netop den detalje, der giver balance i rummet.
Ingen standardmål – kun gardiner efter dine mål og ønsker!

Solens lys er dejligt for mennesker – men ikke for møbler! Det nye transparente rullegardin fra Trendy Gardiner løser problemet:
“Egentlig ville jeg slet ingen gardiner have, men der skulle ske noget, for det er tydeligt at mine møbler tog skade af sollyset. Det transparente rullegardin er en stilren overraskelse, som både beskytter mine møbler mod solen og elegant indrammer stuen.”
Charlotte Strøm, Vedbæk
Guide til priser
Alle priser er pr. stk. og inkl. moms
Prisen inkluderer:

Kombinér gerne størrelser






7 3 4


Vi har fundet knap to håndfulde. 7
Det løse tæppe er fantastisk til at skabe stemning og stil i stuen. Markedet bugner af tæpper til enhver pengepung.
1
Sivana af Emil Thorup Sivana betyder vævning med hånden, og det er lige netop, hvad kollektionen fra Emil Thorup og Garant handler om. Erfarne hænder væver Emils smukke mønstre i fed newzealandsk uld på væve, der ofte er gået i arv gennem generationer. På det store foto ser du Gebo, der i runealfabetet betyder gave. Selve tæppet er i modsætning til resten af serien ottekantet. Størrelser: 140 x 200 cm, 170 x 240 cm, 200 x 300 cm. Tæpperne koster fra ca. 3.700 kr afhængig af stør-
relse i Garants butikker over hele landet.
2
Garden Rug Massimo Copenhagen har netop lanceret Garden Rug i to farver med smukke haveinspirerede mønstre. Her er tæppet håndknyttet i afghansk uld af højeste kvalitet. Tæppet måler 160 x 230. Koster ca. 9.200 kr.
3
Linie Design Tæpper fra Linie Design er dansk design, når det er bedst. Alle Linie Design tæpper er håndvævede i en skandinavisk, minimalistisk stil – og naturligvis er striberne her repræsenteret på flotteste vis. Tæppet her,


2


som vi fandt hos Garant Tæpper, måler 140 x 200 og koster ca. 1.715 kr.
4
Massimo Copenhagen
Her ser du et håndvævet kelim-tæppe, fremstillet efter traditionel metode, så hvert tæppe er unikt. Det er fra Massimo Copenhagen. Tæppet skulle være brandhæmmende og uld-kvaliteten ”skyr” snavs. Tæppet her fås i tre størrelser: 90 x 210 cm, 150 x 210 cm og 180 x 240 cm. Priserne ligger fra ca. 2.500 kr.
5
Louis De Poortere Mad
Men Griff Her ses farver, der mikses og giver et dybt indtryk. Tæpperne fra Louis De Poortere er produceret på Jacquard Wilton væve med bomulds chenille garner. Alle tæpperne har en afslutning, som er lavet i hånden samt har en anti skrid bagside. Der er 6 forskellige farver og 8 forskellige størrelser. Hos Garant ses priser fra ca. 530 kr.

6
RETRO TÆPPE
Mønster og farver er nye og "gamle" på en gang. Tæppet, der fås i to farver, passer perfekt i nutidens bolig.
Hygge i en løber UPS! Hvad nu?
Foran sengen, i entreen, på badeværelset, i børneværelset eller på altanen. Vi kan - FAKTISK - ikke undvære en løber eller måtte i vores bolig
6
Svenske Pappelina
Her er løberen eller måtten i plast. Praktisk både inde og ude og ekstrem holdbar. Linda Richardson står bag Pappeline. Hun besøgte et lille familievæveri i Dalarne i Sverige – og så fik hun ideen til løberen og måtter i plast. I dag fås tæpperne i flotte designs og et væld af farver og størrelser til priser fra ca. 1.000 kr. for en løber og ca. 500 kr. for en måtte i fx 90 x 70 cm.
7
Nantes Lime For bare 165 kr. kan den grafiske måtte/løber her blive din. Den bærer navnet Nantes Lime, og vi fandt den hos Garant.
Når uheldet er ude, så er de vigtigste hovedregler disse:
5


Lad aldrig en plet blive siddende ubehandlet. Jo længere, der går, fra skaden sker til du reagerer, jo mindre chance for at pletten bliver HELT væk igen.
Minimer pletten. Fjern det, som er årsag til uheldet hurtigst muligt. Fx skal du "suge" væske op med en tør klud eller flere stykker køkkenrulle. Det er vigtigt, at du IKKE GNIDER. Væsken skal bare elimineres, så godt som det er muligt.
Nu kan du med lunkent vand forsøge at opløse resten af væsken. Pas på gulvet nedenunder. Så dupper du igen. Fra plettens yderkreds og ind mod midten. Gentag gerne processen, indtil væsken er helt opsuget. Læg et godt lag aviser under pletten, så tæppet kan tørre hurtigst muligt.
Er der tale om genstridige pletter, så skal du overveje: Er tæppet dyrt, så spørg der, hvor tæppet er købt, hvordan du kommer videre. Tør du eksperimentere, så forsøg med lidt pisket skum fra mild, farveløs sæbe/rengøringsmiddel. Husk at skylle godt igen, når pletten er væk.

på terrassemarkiser, pergolamarkiser og ny markisedug ved bestilling inden d. 31. marts.

VINDFØLER*
Ved køb af terrassemarkise med radiostyret motor inden d. 31. marts
* værdi (1.795,-)







Blokhus Teak Havemøbelsæt


Sæt bestående af 1 stk. 3-personers bænk, 2 stole samt flot bord str. 90x170 cm. Alt i massiv kerneteaktræ.
Vejl. 10.496,-



5.999,-





Rørvig Havemøbelsæt

Havemøbelsæt i retrostil. Med hvidt aluminiumsstel og luksus teaktræ. Sættet består af 4 stabelstole og rundt bord på 110 cm der kan foldes sammen.
Vejl. 9095,-

















Hercules 240 Pala Teak


Hercules plankebord (100 x 240) sammen med 6 Pala stabelstole. Alt i solid og ekstra kraftig kvalitet i lækker kerneteaktræ. Vejl. 21.793,-



12.999,-





Super lækker solvogn i det bedste kerneteaktræ. Sammenklappelig og med bakke der kan trækkes ud. L:214 x B:65 x H:35 cm. Længde sammenklappet 114 cm.
Vejl: 2.999,-

1.999,-






Superflot bord med bordplade der er formet som en marguerit. Fremstillet i kraftig kerneteaktræ i den allerbedste kvalitet.









Sæt m/4 stk. Geneve stabelstole samt Nora udtræksbord (120x120/180 cm) i luksus kerneteaktræ. Et bord i superflot kvalitet med smart udtrækssystem.
Vejl: 8.595,-

































































































Teak Havemøbelsæt
Sæt i Classic teaktræ med 6 foldestole og stort ovalt udtræksbord (100x180/240 cm).
Vejl. 5298,-



KØ-TILBUD


2.000,-
SPAR 3.298,-



Teak Havemøbelsæt
Sæt i Classic teaktræ med 4 positionsstole og stort ovalt udtræksbord (100x180/240 cm).
Vejl. 6.695,-

2.500,-
SPAR 4.195,-
























KØ-TILBUD









Classic teaktræ. Teak Foldestol
Vejl: 299,95








Teak solvogn
Vejl. 1.999,-









STARTER













SPAR 199,95
TEAK KØ-TILBUD
TORSDAG D 22.3. KL. 10



KØ-TILBUD


100,-





















Solvogn i Classic teaktræ. L:199 x B:65 x H:37 cm.



Teak Havemøbelsæt
Havemøbelsæt i Classic teaktræ. 1 stk. bord Ø 90 cm samt 4 foldestole. Vejl: 2.999,-






ALLE TILBUD GÆLDER I ALLE VORES BUTIKKER









800,-












SPAR 2.199 ,-



Teak Dækstol




I Classic Teak med kraftige messingbeslag. Med 7 positioner. Vejl. 1.699,-



600,-


KØ-TILBUD

SPAR 1.399,-



















KØ-TILBUD






400,-




SPAR 1.299,-













Vejl: 5999,-
























Hvidt havemøbelsæt i skandinavisk stil. Sættet består af bord (165x90 cm), 2 stole og 1 bænk. (Ekskl. hynder).


Sofa med alustel med sort polyrattanflet og sorte hynder. Vejl: 3699,-

3.699,-













Sofasæt i moduler. Alustel med ekstra kraftig polyrattanflet. Sættet består af 3 hjørnemoduler, 2 midtermoduler og 1 bord inkl. sandfarvede luksushynder.

Vejl: 12999,-










Alustel med kraftig dusty polyrattanflet. Inkl. sorte luksushynder. Sættet består af 1 stk. stor 3-personers sofa, 2 stole og 1 bord med grå nonwood lameller. Vejl: 15999,-











Sættet består af 3 hjørnemoduler, 2 midtermoduler og 1 bord. Alu stel med kraftig sort polyrattan flet. Sammensæt din sofa som du ønsker. Inkl. luksus hynder. Vejl: 10.094,-


































Sættet består af hjørnesofa og bord.Hjørnesofaen er i aluminium og med kraftig sort polyrattan flet. Inkl. grå hynder. Bord i sort polyrattanflet og med bordplade i nonwood. Vejl: 6999,-




















Sættet indeholder 6 stabelstole i sort polyrattanflet og stort bord (90x205 cm) med sort alustel og sorte nonwood lameller.
Vejl: 5499,-


6 stk. sorte stole i sort polyrattan og med indstillelig ryg samt Lima udtræksbord (100 x 205/275 cm) med smart udtrækssystem. I aluminium med kraftig bord




SUPERPRIS
1.999,-
SPAR 3.500,-









SÆT M/6 STOLE 6.999,SPAR 6.294,-












Vejl. 1.499,-

SUPERPRIS
799,-
SPAR 700,-












Solvogn i aluminium med polyrattanflet i sort. Armlæn i lysegrå nonwood. Kan foldes sammen, så den næsten intet fylder.














4 stk. Cebu stabelstole i grå polyrattanflet samt 1 stk. Henry bord (92x150 cm) med sort alustel og ekstra kraftige grå nonwood lameller. Vejl: 5495,-




SÆT M/4 STOLE
2.999,-
SPAR 2.496,-
















Sæt m/4 stk. grå stabelstole i polyrattanflet samt superflot bord (Ø 110 cm)med bordplade i smuk mosaik af kakler. Stellet er fremstillet i ekstra stærkt stål.
Vejl: 6295,-




Stole i elegant retro-stil. Fremstillet i polyrattan-flet på galvaniseret stålstel. Flere farver og varianter.
Vejl: 1099,-



















SÆT M/4 STOLE
3.499,-
SPAR 2.796,-





NU KUN











699,SPAR 400,-





Brændeovne | Pejseindsatse | Træpilleovne | Stålskorstene |































Plant gerne dine skærmplanter ud mellem stauder og andet. Det giver dit bed en fantastisk charme.







Skærmplanter er et hit. De giver blomsterbedene lethed og ynde, de er perfekte til havebuketter, og de tiltrækker nyttige insekter og bier.
Skærmplanter står øverst på ønskesedlen i mange haver, men for at få ønskerne opfyldt, er det ofte nødvendigt at så planterne selv. De enårige skærmplanter, der er gode som sommerblomster, ses nemlig sjældent i handlen til udplantning.
Det gør nu ikke så meget, for det er ikke svært at dyrke dem selv. Frøene kan sås direkte på friland i april-maj, men du får hurtigere fornøjelse af planterne, hvis du forspirer dem i vindueskarmen nu og planter de små planter ud til maj.
Livet begynder i vindueskarmen
Ud over frø skal du bruge potter eller bakker til at så i samt gennemfugtet spiremuld.
Fyld spiremuld i bakkerne, jævn overfladen ud og så frøene med god afstand. Giv frøene et lille tryk, så du er sikker på, at de er i god kontakt med jorden.
Dæk så frøene med lidt mere spiremuld og tryk let til igen, før du vander. Dæk bakken med film eller put den i en plastikpose, så der er styr på fordampningen og dermed ikke så stor risiko for udtørring.Frøene spirer fint ved stuetemperatur,
så sæt bakkerne i en vindueskarm, der ikke vender direkte mod syd.
Når planterne gror Skærmplanter er generelt lidt længe om at spire, men i løbet af et par uger dukker de spæde, grønne kimplanter frem. Da er det bedst at justere lidt på forholdene.
Der er ikke meget lys på denne årstid, og kombinationen af et lavt lysniveau og den høje stuetemperatur resulterer nemt i lange, ranglede planter. Efter spiring skal planterne stå så lyst og så køligt som muligt, selvfølgelig uden at de udsættes for frost.
Når de spæde planter har fået deres første løvblade, det vil sige de blade, der kommer efter de to første kimblade, er tiden inde til at plante dem om til hver deres lille potte, så de ikke skal slås om lys, vand og næring med naboplanten.
Skil forsigtig planterne fra hinanden og plant dem på ny i gennemfugtet spiremuld. Stil dem igen lyst og køligt og sørg for, at de ikke tørrer ud. Når risikoen for frost er overstået hen i maj, er de klar til udplantning i havens bede.
Tekst og fotos: Lotte Bjarke

BLOMSTERKØRVEL
sås i små potter i vindueskarmen.
Skærmplantefamilien er en stor familie med blomsterstanden som det gennemgående kendetegn. Skærmplanternes blomsterstand er bygget op af tusindvis af bittesmå blomster samlet i små skærme, der tilsammen danner den store skærm.


HAR DU FLERE typer til forspiring, så husk tydelig markering, så du ved, hvad der er hvad.
SKÆRMPLANTER
kan være lidt længe om at spire. Godt med lys sikrer, at de ikke bliver for ranglede.


PAS PÅ de spæde planters rødder, når du skiller dem ad for at give dem mere plads.
Tre planteportrætter
1 2 3
Gulerodsblomst, Daucus carota, er en forædlet sort af vild gulerod, der udmærker sig ved lette skærme i rosa, vinrøde og hvide nuancer. Den bliver 60-100 cm høj og blomstrer hele sommeren.
Tandstikkerurt, Amni visnaga, er en kraftig plante med filigranagtigt løv og hvælvede skærme, der først er grønne men efterhånden bliver hvide. 75-100 cm høj og med dejlig, langvarig blomstring.
Blomsterkørvel, Orlaya grandiflora, er en usædvanligt storblomstret skærmplante med hvide kniplingeblomster midt på sommeren. Den bliver 40-60 cm høj. Sår sig selv, når først du har den.























































Der er opstået en myte om, at det ikke er muligt at male tegltag. Men der ndes faktisk to typer af tegl - og det er kun lertegl, der ikke er egnet til at male. Betontegl, som mange boligejere har liggende på deres tag, kan faktisk nemt vedligeholdes.

kan et slidt tag sagtens klare min. 15 år mere, efter vi har behandlet det,« forklarer Jannick fra Tag Rens A/S
Økonomien – hvad koster det?

»Du vinder hurtigt 15 år på dit tags levetid, hvis du får det renset og malet eller imprægneret. Et slidt betontegltag bliver ligesom en svamp, der bare står og suger nedbør til sig. Du kender det sikkert fra en ubehandlet betontrappe,« forklarer Jannick fra Tag Rens A/S, så derfor er det yderst vigtigt at taget bliver forseglet efter rensningen med enten Maling eller imprægnering.


Tidligere tal viser, at over 200.000 betontegltage er under nedbrud, men at de sagtens kan reddes, hvis de får den rette behandling.

»Mange parcelhusejere tænker ikke på, at et betontegltag jævnligt bør renses og males. Betonteglen skal ligesom udendørs træværk beskyttes imod slidtage fra vind og vejr. Får det den rette behandling,


















Det kan godt betale sig økonomisk at få renset og malet taget i stedet for få lagt et nyt. En rensning og maling af dit betontegl koster kun en tiende del af, hvad et nyt tag koster.
»Vi kan rense og male kundens tag på kun to dage, så kunden oplever minimale gener, når vi kommer ud og ordner deres tag.« forklarer Jannick fra Tag Rens A/S.


Gennem de seneste 19 år har Tag Rens A/S ordnet betontegltage i Storkøbenhavn og Nordsjælland, og tendensen er klar. Flere har simpelthen fået øje på dusen og vil gerne spare penge. Tag Rens A/S oplever et stigende antal kunder, som vælger at vedligeholde deres tag fremfor at ofre ere hundrede tusinde på et nyt.
Dit tag kan få den farve, du ønsker!



Hvis du er ked af den farve, dit tag har, eller ville ønske at du havde et tegltag med højere glans, så fortvivl ikke. Det er faktisk ligetil at få ændret farven på dit tag - og det kan også sagtens males med højglans-maling, så det står som nyt.












































































DE STORE FRØ af valsk bønne kan sås fra begyndelsen af april i 5-10 centimeter dybe render.

DE STORE BÆLGE høstes, når de begynder at blive lidt bløde, og du tydeligt kan mærke de store frø inden i.

HER SES FRØENE: De pilles ud af bælgen, smuttes ud af den hvidlige hinde og blancheres.
Valsk bønne er botanisk set ikke en bønne.
Det er en fordel, når du skal dyrke den, for mens bønner er kendt for at være kuldskære, og derfor først kan sås i begyndelsen af juni, så er valsk bønne ikke sart.
Derfor kan du sagtens så valsk bønne fra begyndelsen af april og høste allerede i juli-august.
Valsk bønne er meget smukke planter med glat, blågrønt løv og store, iøjnefaldende sorthvide blomster. Faktisk er de så fine, at de kan bruges som

Det er nemt at dyrke valsk bønne – som du måske kendersom hestebønne.
Bønnen er noget af det lækreste, du kan dyrke i haven.
dekorative krukkeplanter, lige så vel som de kan dyrkes mere traditionelt i en køkkenhave eller et højbed. Frøene er en sprød og saftig delikatesse med en smag a la ærter.
Valsk bønne bør ikke spises rå!
Støt de høje planter Valsk bønne holder af jord, der har fået masser af kompost. Begynd med at lave 5-10 cm dybe riller i jorden til de store frø. Vand i bunden af rillen, før du sår. Planterne bliver kraftige,
så de skal have god plads. 30-34 centimeter mellem planterne og mellem rækkerne er passende. Frøene spirer hurtigt, og så kommer der fart på. Efter blomstringen begynder planten at danne bælge. Det bliver den ofte lidt toptung af, og så vælter den let. Derfor skal du sørge for en form for støtte til planterne, der kan blive næsten en meter høje. En stok til hver eller et opbindingssystem som det, der bruges til
hindbær, hvor man trækker en tråd mellem to pæle til at holde på planterne, er gode løsninger.
Samler selv kvælstof Valsk bønne kan ligesom bønner og ærter fiksere kvælstof fra luften, så samtidig med at planterne leverer lækre bønner, kvælstofgøder de jorden i køkkenhaven. Derfor er det ikke nødvendigt at gøde planterne. Til gengæld skal du huske at grave dem ned i jorden, når høsten er forbi, så der ikke går næring til spilde. Du kan for eksempel så spinat i rækken,

1
De store grove bælge høstes, når de begynder at blive lidt bløde, og du tydeligt kan mærke de store frø inden i.
2
Tag de store frø, der ligger blødt i det fineste hvide filt, ud af bælgen, der ikke er særlig spiselig.
3
Frøene ligger i en hvidlig hinde, der heller ikke er spiselig. Pil hinden af med
når planterne er væk engang i august. Så vil spinatplanterne profitere af den indsamlede kvælstof.
Bladlus elsker
valsk bønne
At valsk bønne er en delikatesse, vil de sorte bedebladlus desværre godt skrive under på. Planterne tiltrækker dem som en magnet, så de nærmest kommer til at sidde i lag i skudspidserne, hvis ikke man er over dem fra starten. Spul lusene af med vandslangen med hyppige mellemrum, så de ikke svækker planterne. Hvis du har overset et angreb, efter at planten har sat bælge, kan du med fordel klippe de hårdt angrebne skudspidser af og dernæst fortsætte med de kolde afvaskninger.
Tekst og fotos: Lotte Bjarke
en urtekniv eller giv frøene et opkog, så kan de smuttes ligesom mandler.
4 Kog frøene i 30 sekunder, så er de klar til at spise. De smager skønt, nærmest som ærter.
5 De er lækre vendt i olivenolie og drysset med salt og perfekte til en hurtig, sommerlig pastaret.

Valsk bønne er gourmet sorterne af hestebønne, der traditionelt bruges til dyrefoder. I virkeligheden er valsk bønne botanisk set slet ikke en bønne, men en vikke. Vicia faba hedder arten på latin, mens bønne hedder Phasaeolus.











Altid gode tilbud til haven



Bark- og træflis • Muldjord • Højbedsmuld • C-muld • Pottemuld Rhododendron spagnum • Topdressing • Sten, grus og granit. Hurtig levering af varer på vognlæs og i bigbags.
Du kan også afhente selv på pladsen i Lynge.
Åbningstider: Man. - fre. 7.00 - 16.00 • Lør. 9.00 - 13.00
Lynge Naturgødning
Slangerupvej 16 · 3540 Lynge
Tlf. 48 18 73 50 · www.l-n-g.dk
Ren & frisk luft i din bolig med energieffektivt anlæg fra vores danske partner
Professionelt udført og materialer af høj kvalitet som overholdergældende krav.
Leveres som selvbyg med vejledning og tegning eller som nøglefærdigt og køreklart projekt.
Mitsubishi luft/luft varmepumpe med 5 års garanti
Pris fra 11.995,- inkl. standardmontage og moms
Vi udfører kontrol af funktion & standardservice på alle luft/luft varmepumper for 800,inkl. moms.
HUSK at service af din varmepumpe er vigtig for energirigtig & sikker drift i mange år.
ER DIN BOLIG UTÆT? Der kan være mange penge at spare
Pris fra 995,- inkl. moms
Termografering & Trykprøvning (blowerdoor-test) er et effektivt værktøj til at hurtigt afsløre og dokumentere skjulte fejl og mangler, det kunne være varmetab på utætte bygninger, dårlig isolering, dårlige vinduer, fugtproblemer med fare for skimmelsvamp, farlige elinstallationer, fejl på gulvvarme, fejl på solceller og meget mere.
Me dlem af : Forhandler af : Certificeret/godkendt af :


Pendler
Ø16 cm 499,Ø19 cm 649,-

Dynamo fås i mange farver. Vælg lampen til bord, gulv, væg eller en pendel.
Se meget mere på www.lamperoglys.dk

Bordlampe 499,Væglampe 499,-

Lampeland Lyngby på Facebook www.lamperoglys.dk





lørdag den 24. marts og søndag den 25. marts mellem 10.00-15.00





Vinduer, der er mærket med kvalitetsmærket DVV, giver dig en sikkerhed for, at vinduernes kvalitet er i orden, og at de er velegnede til det danske klima.
Du har desuden adgang til en offentlig anerkendt klagebehandling.
Tjek, hvor mange års garanti, leverandøren giver på vinduet – og hvad garantien præcis indeholder.



Vi rydder ud i følelser og fordomme – og giver dig opdateret fakta, så du kan bestemme materialet til dine nye vinduer.
Skal du i gang med at skifte vinduer i dit hus, vil du hurtigt skulle vælge: Skal de nye vinduer være af træ, plastik, eller af træ/alu?
Der er gode argumenter for alle typer. Så valget skal tages ud fra stil, pengepung og hvor meget du vil vedligeholde.
Vinduer udvikler sig løbende, derfor er det vigtigt at være opdateret med de nyeste facts.
Husk stilen
Husk, at vinduet skal matche dit hus. Det gælder især, hvis du bor i en klassisk hustype, fx en patriciervilla eller en murermestervilla. Her er det helt afgørende, at du vælger vinduer, der går godt i spænd med boligens oprindelige arkitektur.
Hvis du overvejer at foretage store stilændringer, er det en god idé, at du rådfører dig med en arkitekt eller anden fagkyndig først.
Vælg farve
Vinduer fås i dag i et væld af forskellige farver. Det giver mange nye muligheder for at skabe det perfekte facade-look, men her er det vigtigt at overveje farverne grundigt, inden du tager en beslutning. På et moderne hus har du rigtig gode muligheder for at lege med farverne, men på ældre huse, bør du have husets originale stil og arkitektur med i overvejelserne.
Vinduerne skal sidde på dit hus i mange år, så pas på med at hoppe med på en farvetrend.
Det er meget vanskeligt –nærmest umuligt – at ændre farven på plastikvinduer og træ/alu vinduer.
Tænk på at skabe sammenhæng. Fx kan du lade vinduets farve gå igen på døre, udhæng, sokler, carport eller lignende. Farven bør desuden komplementere både tag og facade.
Leg gerne med kontraster og skeln mellem kolde og varme farver. Tænk på, at vinduesrammerne skal gå godt i spænd med huset, men de behøver ikke nødvendigvis at forsvinde i facaden (medmindre du gerne vil skabe den effekt).
Kilder, tekst og fotos: Jydsk Vindueskompagni, Velfac, Velux, Lise Mortensen m.fl.
Fortsættes næste side
Alle vinduer på det danske marked er omfattet af Energistyrelsens energimærkningsordning, som går fra A til F, hvor A er den bedste. I dag skal alle nye vinduer have energimærkning B eller bedre.
Fra ca. 2020 skal alle nye vinduer have energimærkning A.
B-mærkede vinduer har to lag glas og isolerer godt (efter de nuværende standarder).
A-mærkede vinduer har tre lag glas og isolerer bedre end B-mærkede vinduer.
A-mærkede vinduer er energineutrale. Det betyder, at de lukker mindst lige så meget varme ind i huset, som de lukker ud – også i de kolde måneder.
A-mærkede vinduer er lidt dyrere end B-mærkede vinduer. Til gengæld giver de besparelser på varmeregningen.


Træ/alu-vinduet er et klassisk trævindue in de. Udvendigt er træet belagt med pulverlakeret aluminium.Det betyder, at vinduet er vedligeholdelsesfrit udvendigt, men med tiden skal males ind- vendigt. Her er trækvaliteten vigtig: Det er bedst med en høj procentdel af kernetræ.


Vinduer af fyrretræ har været brugt siden 1700-tallet.
De har "ægte charme".

Tjek også, at pulverlakeringen er certificeret: GSB International sikrer, at lakken holder i mange år.
OBS! Der findes to typer træ/alu-vinduer. På den ene type er aluminiumsprofilerne monteret, så vinduet kan skilles ad og en rude kan skiftes. I den type, hvor aluminiumsprofilerne er bygget ind i vinduets konstruktion, er det vanskeligt at skifte ruder.
Prismæssigt ligger træ/alu vinduer som regel blandt de dyreste vinduer.
VEDLIGEHOLDELSE
Består i smøring/justering af hængsler og beslag ca. en gang årligt. Udvendigt er der ingen vedligeholdelse, indvendigt skal vinduerne passes og males som trævinduer.
FORDELE
● Alu-beklædningen forlænger vinduets holdbarhed og gør materialet vedligeholdelsesfrit.
● Vinduet kan fås i en slank konstruktion (smalle rammer og karme), der giver et større rudeareal, hvilket giver mere dagslys i rummene og et bedre udsyn.
ULEMPER
● Elementerne kan ikke males udvendigt, hvis du ønsker dine vinduer skal have andre farver.
● Hvis alu-profilerne er bygget sammen med vinduets konstruktion, kan det være vanskeligt at skifte ruder.
Læs de tekniske specifikationer på vinduet. Et væsentligt tal er hvor mange procent kernetræ, der er brugt. Det ligger typisk mellem 60 og 90%. Kernetræ har et naturligt indhold af harpiks, der sikrer træet naturligt imod råd og svamp. Tjek også, om træet er scannet for harpikslommer og er frit for synlige knaster. Endelig er det vigtigt, at træet er grundbehandlet mod svamp og råd.
Du skal tage stilling til, om vinduerne skal være malede, når du modtager dem. Det koster ekstra – men sikrer, at træet er malet under korrekte forhold uden fugt.
Af de tre materialer er vinduer i træ de billigste. Men husk, pris følger normalt kvalitet.
Trævinduer skal tjekkes en gang om året. Husk, solsiden skal males oftere end skyggesiden. Mal dem med min. fem års mellemrum – første gang fem år efter køb.
● Naturmateriale, der ser naturligt ud og passer ind i de fleste typer byggerier.
● Nemt at skifte farve ved at male elementerne.
● Kan slibes, spartles og males.
● Som regel et prisstærkt materiale.
● Skal vedligeholdes og males jævnligt, Elementerne skal males ca. hvert 5. eller 6. år.
● Hvis elementerne ikke vedligeholdes korrekt, reduceres levetiden markant.
Her er ovenlysvindue og tagaltan bygget sammen i ét, og monteret i det skrå tag. Når den er lukket, har du glæden ved det traditionelle ovenlysvindue, hvor dagslyset får lov til at strømme ind i overetagen. Når den åbnes, skaber den plads i højden og giver dig panoramaudsigt og inviterer udelivet indenfor. Tagaltanen sikrer rummet et stort lysindfald, perfekte muligheder for udluftning og en hyggelig tagaltan med fuld ståhøjde. Løsningen er fra Velux.


I dag er det svært at skelne mellem kvalitetsvinduer af plast og trævinduer. Ofte er det en smagssag, om man vælger plast eller træ. Plastvinduer kan bestilles i mange farver – og kan være én farve udvendigt og en anden farve indvendigt. De kan enten være malede eller belagt med en form for folie. Begge overflader er stærke og modstandsdygtige over for ridser og tryk.
Plastvinduer er miljørigtige. Materialet indeholder ikke tungmetaller og gamle vinduer kan genanvendes som plast.
Nogle plastikvinduer har træ-kerne, der er belagt med polyuretan. Tjek altid, at vinduerne er UV-modstandsdygtige, så solen ikke påvirker plasten. Kvalitetsplast holder farven i mange år.
Plastik er ikke kuldeledende og skaber ikke kuldebroer. Derfor isolerer plastvinduer mindst ligeså godt som vinduer i andre materialer. Som en ekstra bonus er plastvinduer ekstra gode til at undgå kondensdannelse på indersiden af ruden.
Ved brand er der forskel på, hvor sikre plastvinduer er. Nogle typer er lavet af et selvslukkende materiale. Tjek dette i materialebeskrivelsen.
Prismæssigt ligger anskaffelsesprisen for plastvinduer typisk mellem træ og træ/alu. Hertil kommer, at du slipper for at bruge penge på vedligeholdelse.
Består i smøring/justering af hængsler og beslag ca. en gang årligt. Vask rammer og karm, når du pudser vinduer, og polér eventuelt med autovoks.
● Du undgår råd og svamp – vinduerne er vedligeholdelsesfrie.
● Vinduet kan nu fås i en slank konstruktion (smalle rammer og karme).
● Et ovenlysvindue, der er svært at komme til, vil være oplagt i plastik.

● Hvis der kommer en ridse, kan den ikke repareres. Små ridser pudses væk med et slibemiddel.
● Det kan være svært, hvis ikke umuligt, at male plastvinduer, derfor kan du ikke ændre farve på dine vinduer efterfølgende.
















– og holder længere, men samtidig kan du få både solkrog og opbevaring
Byg carporten
så stor, at der er plads til mange ting og flere funktioner under tag. Det giver uvurderlige muligheder.
Har du planer om at bygge carport, så tænk over, om du ikke også kunne bruge lidt mere plads under tag, når I alligevel er i gang med at bygge.
Den nye trend for carporte er, at de er store, og at de er inddelt i flere afdelinger og/eller rum. For der er mange ting, der er ganske rare at få under tag, afhængigt af, hvordan familien er sammensat.
I børnefamilier kan der være behov for et tørt og trygt sted at stille barnevognen – både når der er én, der sover middagslur i den – og når den skal opbeva-
res. Der kan også blive plads til trehjulede cykler, cykelvogn –og senere små og store cykler, rulleskøjter, surfbræt – til hele familien.
Vasketøjet er også rart at få under tag, og har I brændeovn eller pillefyr, er der sikkert også brug for plads til oplagring.
Når vi nu er i gang, så kan der måske også blive plads til et regulært skur med plads til havemaskiner og værktøj.
Selvfølgelig skal der også være plads til familiens bil eller biler – og evt. også en trailer.
En del af væggene eller opdelingen kan udfærdiges, så de
forholdsvis nemt kan flyttes eller fjernes, i takt med, at familiens behov ændres.
Kom tørskoet ind Naturligvis vil grunden og husets placering lægge praktiske begrænsninger for, hvor carporten kan bygges.
Hvis der er flere muligheder, er det vigtigt både at have det praktiske og det æstetiske med i overvejelserne, når I vælger, hvor carporten skal stå.
Tænker I på det praktiske, er multirummet/carporten et ekstra rum til huset, og det skal derfor ikke placeres langt fra
Få overblik over, om der findes klausuler i lokalplanen, som kan betyde noget for byggeriet.
Husk at anmelde byggeriet til kommunens tekniske forvaltning.
Vær opmærksom på højdeog afstandskrav til skel.
Tag højde for regnvand, kloak og terrænets hældning.
Undersøg muligheden for strøm i forbindelse med tilslutning af LED-lys.
Undersøg jordbundsforhold (muld, opfyld, store sten, trærødder mv.)
Få overblik over, hvad der ligger i jorden (kabler, gas, vand, kloak mv.)

HER BETYDER en rummelig løsning, at "bagsiden" af carporten er blevet til en overdækket terrasse, der kan bruges stort set hele året.
ET OVERDÆKKET cykelskur er GULD for de familiemedlemmer, der ikke sidder bag rattet.

hoveddøren, for det er rart og praktisk at kunne gå tørskoet ind i huset.
Hvis carporten skal stå helt tæt på huset eller evt. bygges sammen med huset, er æstetikken ekstra vigtigt. Hvilken tagtype? Buet tag, fladt osv. , og hvordan kommer taghældningen til at passe? Hvilke materialer passer til huset? Carporten kan enten bygges i samme materialer som huset – og dermed blive en flot integreret del af husets arkitektur. Eller du kan vælge en carport i helt andre materialer – som på sin egen stilfulde facon kan
MINIMALISTISK og elegant. Udviklingen af carportløsninger følger bestemt med den moderne boligs arkitektur.


skal indrettes, er professionelle cykelgafler en god investering. Det giver ro og orden.
understrege husets arkitektur. Herudover er det især de små ekstrainvesteringer som eksempelvis integreret belysning, velplacerede cykelholdere, forlænget tag, isoleret redskabsrum, vedligeholdelsesfrie materialer og eksklusive farvevalg, der kan give rigtig god "value for money", fordi der er tale om relativt små investeringer med en meget stor afsmittende effekt på opfattelsen af hele huset.
Kilder, tekst og fotos: Lyngsøe, Dansk Stål Design, Lise Mortensen
1
Overvej materialevalget. Vælger du træ, skal det vedligeholdes. Galvaniseret stål er vedligeholdelsesfrit, det er de fleste typer nonwood også.
2
Overvej størrelsen på jeres nye carport/multirum. Ekstra kvadratmeter er billige, når byggeriet alligevel er i gang. Det er en god idé at få taget stort nok. Indretningen kan komme i næste omgang.
3
Husk at budgettere med de ekstra omkostninger, byggeriet fører med sig – fx flisebelægning og belysning.
4
Undersøg marked og muligheder, før du beslutter, hvordan din løsning skal se ud.

Taget på din carport er et rigtigt godt sted at lægge solceller. Det griber ikke ind i selve husets tagkonstruktion – og skæmmer ikke husets arkitektur. Samtidig kan et stort
multirum give plads til et ret stort solcelleanlæg, der kan supplere husets elforbrug.
En anden mulighed er et mindre anlæg, der udelukkende leverer el til lys i carporten
Det er en god idé at overveje, hvad du skal bruge dit redskabsrum til. Hvis du ønsker at opbevare ting, som ikke tåler frost, kan du vælge at isolere redskabsrummet.
Du skal dog være opmærksom på, at et isoleret redskabsrum ikke er lig med et frostfrit rum. Der skal tilføres en varmekilde, ligesom i huset.
Denne varmekilde, kan være et panel med luft-solvarme – som på billedet – som vil forbedre indeklimaet, give ekstra varme og ventilere redskabsrummet.
og evt. til varme i skuret. Det er klart, at retningen på taget har stor betydning – ligesom taget ikke må ligge i skygge fra hus, træer eller andet. Så søg rådgivning, før I projekterer solcel-

ler. Nogle solcellepaneler lægges oven på taget, andre kan i sig selv fungere som tag – og leveres med integrerede tagrender og led-belysning.


















Er dit tag blevet gammelt og slidt efter i mange år at være udsat for skiftende, hårdt og belastende vejr, så lad JR SERVICE give dit tag nyt liv med tagmaling. Taget er husets største flade, og udover vigtigheden af et tæt og stærkt tag, så har det også enorm betydning for æstetikken.
Inden vi går i gang med malerarbejdet, foretager vi en gennemgribende tagrensning med vores specialudstyr, så taget er helt frit for mos, alger og anden belægning.


Herefter males taget to gange med en særlig tagmaling i en standard eternitfarve efter kundens valg. Det giver et nyt ”slidlag” på det gamle tag med en tykkelse på over 100µ, hvilket er det dobbelte af, hvad der ligger på nye asbestfrie tagplader.
Er dit tag uegnet til renovering, giver vi et tilbud på total udskiftning med ny eternit – med garanti et godt tilbud..!

5 ÅRS GARANTI
Vi tilbyder en algerens, der ikke blot fjerner de eksisterende alger – den forebygger også ny vækst og sikrer, at dit tag kommer af med den fugt, der kan skabe store problemer.
Hos JR SERVICE anbefaler vi en algerensning hvert år for at sikre en pæn og holdbar overflade. Det er

en billig måde at sikre sig et flot og stærkt tag til de næste mange år.
De fleste af vores kunder har fundet ud af, at en årlig algerensning er en rigtig god investering, og for at gøre det endnu lettere for dig, tilbyder vi en 5-årig serviceaftale. Ring for mere info herom!


I mange år har granulatbelagte DECRA tage været et meget populært alternativ til andre typer af tagbelægning som tegl og fibercement når taget skal udskiftes.
Vi har hos JR SERVICE gennem en årrække udviklet en særlig teknik til skånsom rensning og vedligehol-

delse af disse tagoverflader - til stor glæde og lettelse for vore mange kunder.
Vi tilbyder derfor et fuldt koncept, hvor vi både afrenser taget og sørger for årlig vedligeholdelse, så overfladen forbliver ren og pæn i årene fremover..!

Er dine fliser fyldt med alger, mos eller flisepest? Så har JR SERVICE løsningen..!
Dine fliser er, lige som dit tag, dit og husets visitkort udadtil. Så når resten af huset er velholdt, er det trist hvis grimme fliser løber med opmærksomheden.
Vi har mange års erfaring med nænsom, men effektiv rensning af alle
typer flise- og gangarealer. En efterfølgende algebehandling er altid inkluderet i prisen, men ønsker du en dybdegående imprægnering, tilbyder vi gerne dette mod merpris. Et abonnement på årlig vedligehold med algemiddel, fjerner byrden fra dine skuldre og holder dine fliser rene og pæne år efter år.
Se flere ideer på idenyt.dk/laser ideer

Karen fra Vemmelev har fundet på at genbruge gamle stegepander som under skåle til sine undendørs krukker. Panderne finder hun på loppemarkeder til billige penge. Håndtaget tages af, og panden males i ønsket farve. Panderne er ideelle, fordi de klarer al slags vejr og tilmed er de dekorative. Vi siger tak for ideen og kvitterer med udgavens læserpræmie.
Da vi havde 21 børn til fødselsdag, fik de hver en plastpose med deres navn på, da de ankom efter skole. I posen lagde de taske, jakke og sko m.m.. På den måde var det nemt for dem at finde deres egne ting igen, da festen var forbi.
Lone, Horsens
Jeg er alene, men ville gerne flytte møblerne rundt i stuen. Jeg fandt på at lægge store badehåndklæder under de tunge ting. Nu kunne jeg trække dem rundt ved egen hjælp.
Birgitte, Vordingborg



Sien fra sildebøtten er perfek te som dræn i bunden af dine krukker.
Lotte, Stensved
Et par solide klemmer, der kan gå i opvaskemaskinen er perfekte, når pita-brødet skal fyldes. Og så er fyldte pitabrød gode til madpakken. Charlotte Brunsgaard

Send din idé – og helst et foto, der viser ideen i praksis til os.
Du kan maile og vedhæfte et eller flere fotos til ideer@idenyt.dk. Husk tydeligt navn og adresse på din mail. Alle ideer, der vises her på siden med foto modtager udgavens læserpræmie. Brug af ideer må ske på læserens eget ansvar.
Til udgavens bidrag har vi en funktionel beskærersaks fra Fiskars. Saksen kaldes PowerGear.
De skarpe, rustfri stålblade af høj kvalitet, FiberComp™-konstruktion og et unikt, roterende Softgrip™-håndtag kombineret med ekstra hårde blade sikrer et let, præcist og sikkert klip. Beskærersaksen har en

En klemmepose om halsen, gør det nemmere at hænge tøj op. Fold et stykke stof. Klip huller som vist på forsiden og sy et bånd på, så posen kan bindes om halsen. Nu er klemmerne lige ved hånden.
Peter, Silkeborg

Et jern til snavset
Når jeg renser sandfanget ved mine nedløbsrør, bruger jeg skuffejernet. Det kan komme helt ned i bunden og blade, jord m.m. skrabes op. Anders Favrbo, Vanløse





































































Få den hos din lokale forhandler






FLOTTE TIL FORÅRET


Grimme belægninger på fliserne skurrer i øjnene og tager glansen af havens helhed. Sådan behøver det ikke at være, for med Borup Flise Rens er det blevet meget lettere at komme ”flisepest” til livs, og give dem deres naturlige glød tilbage. Borup Flise Rens er effektiv, fordi den renser helt i dybden. Prøv selv – det er nemt og enkelt.
















RENS AF VED AT FØRE PÅ
Med Borup Afrenser kan du effektivt fjerne skidt og snavs fra træværk, fliser, tagplader, sokler, facader m.m. TIPS & TRICKS: Påfør Borup Afrenser med en svamp, børste, vandkande eller havesprøjte og lad det tørre. Inden eventuel efterbehandling af rengjort overflade, børstes med stiv børste og rent vand.
GIV STEN DET GLATTE LAG
Rene sten og fliser pynter, men hvis du vil beholde dem flotte, skal du efterbehandle dem med Borup Sten og Flise Imprægnering. Det giver en vandafvisende overflade, så de er lette at holde. TIPS & TRICKS : Brug en havesprøjte, men vent til fliserne er helt tørre for at få det bedste resultat.










GRILL & OVN RENS I EN FART
De fleste har stået med en ovn eller grill, der har brug for en rengøring. Med Borup Power Grill & Ovn Rens får du et hurtigtvirkende og effektivt rengøringsmiddel, der sikrer rene, skinnende overflader.
BRUG DEN RIGTIGE SÆBE
Sæbe er ikke bare sæbe, og det gælder også, når du skal vaske dine vinduer. Her skal du bruge en effektiv sæbe, der skummer godt og ikke løber. Prøv selv Borup Power Vinduessæbe og få rene vinduer helt uden striber.


KØKKENRENGØRING FRA A-Z




Dit trætte træværk kan sagtens få gløden igen, og det kræver sikkert bare en omgang Borup Træ Rens. Du kan bruge det på fx havemøbler, terrasser, hegn, carporte og døre, hvor træet er blevet gråt, jordslået og kedeligt. TIPS & TRICKS: Kom koldt vand på overfladen og påfør fortyndet Træ Rens med en blød børste. Lad det virke i 5-10 min. og vask så af med en en hård skrubbebørste.

Der kan hurtigt samle sig snavs og fedtede fingre på overfladerne i et køkken. Med Borup Power Køkken Rengøring får du rene og skinnende overflader helt uden brug af farvestoffer og parfume.
Find flere gode råd på




















GØR RENT UDE, SOM DU GØR INDE
Giv de udendørs overflader nyt liv med Borup Universal Hus Vask. Det velduftende og effektive rengøringsmiddel opløser hurtigt snavs og smuds, så både facade og døre står flotte og skinnende. TIPS & TRICKS: Påfør Borup Hus Vask på udendørs flader med en klud. Skyl efter med rent vand.

Hvis du har brug for tips og gode råd, så ’like’ os på Facebook eller tilmeld dig vores nyhedsbrev på borupkemi.dk




EN PORCHETTA
er luksus i hverdagen – dog uden at vælte økonomien. Sætter du den sammen med appelsindesserten har du et godt bud på en familiemiddag. Her er den serveret med ovnbagte kartofler, tomater og rødløg.
Det er en god idé at bruge et stegetermometer her. Stegen er færdig ved 70° TIPS

Tip
Du kan også købe porchettaen færdig til stegning. Tal med din slagter.


Porchetta, ovnbagte kartofler og tomatsauce
Af Ulla Karlström
6 PERSONER

Porchetta
1 kg nakkefilet
300 g tomater
½ tsk. salt · Peber
5 kviste frisk rosmarin
1 fed hvidløg
1 usprøjtet citron
1 dl bredbladet persille
100 g pancetta (bacon)
2 spsk. olivenolie
1 helt hvidløg
Tomatsauce
½ spsk. sukker
2 dåser tomater
1 tsk. salt, peber efter smag
1 spsk. olivenolie
1 løg
Ovnbagte kartofler og rødløg
1 kg aspargeskartofler
(eller små kartofler)
3 rødløg
1 tsk. salt, peber efter smag
2 spsk. olivenolie
100 g rucolasalat
Vi går mod lyset og har brug for alle de vitaminer, vi kan hente. Appelsiner med gode C-vitaminer er en velkommen vare i denne middag.
1
Sæt ovnen på 125°. Afpuds kødet, og skær et snit på langs af stegen, så den foldes ud til en stor plade. Krydr med salt og peber på begge sider.
2
Hak rosmarin fra 2 kviste, og hak hvidløgsfedet fint.
3 Bland rosmarin, hvidløg, citronskal og persille. Fordel det over kødet.
4
Læg pancettaen på. Rul sammen, og snør.
5
Læg stegen i et ovnfast fad, og stik et stegetermometer i midten. Læg 3 hele rosmarinkviste ovenpå. Del det hele hvidløg i både, og pil skallerne af. Læg hvidløgsfedene ved siden af kødet.
6
Tilbered stegen midt i ovnen. Skru ned til 70° og giv den ca. 2 ¼ time.
7
Læg tomaterne ved, når der er 10 min. tilbage af stegetiden.
8
Tag porchettaen ud, ogdæk løst med alufolie. Skru ovntemperaturen op til 250° (til kartoflerne).
9
Skær porchettaen i skiver. Drys rucola over kartoflerne, og server med tomatsauce.
1
Skrub kartoflerne, og halver dem. Pil rødløgene, og halver dem.
2
Læg kartofler og løg i en bradepande. Krydr med salt og peber. Hæld olie over. Bag midt i ovnen, ca. 20 min.
1
Pil løget, og hak det fint, Steg det i olie ca. 5 min.
2
Tilsæt sukker, tomater, salt og peber, og lad saucen koge uden låg, ca. 10 min.
En appelsin dækker næsten dit dagsbehov for C-vitamin. Sam- tidig styrker du immunforsvar.dit TIPS





Tina Scheftelowitz
12 PERSONER

SÅDAN GØR DU
1
Sæt ovnen på 150° (varmluft: 135° ).
2
Pisk æggehvider, eddike og sukker med en elpisker, til massen er tyk og blank, (ca. 5 min.).
3
Hak mandlerne groft. Beklæd 1-2 bageplader
med bagepapir, og drys let med mel.
4
Fordel æggehvidemassen
jævnt på bagepapiret i 2 cirkler på 2-3 cm’s højde. Drys hakkede mandler på bundene.
5 Bag bundene, til de er sprøde, (ca. 1 time og 10 min.).
6
Afkøl ved stuetemperatur.
1
Flæk vaniljestangen på langs, og skrab kornene ud. Kog vand, sukker, vaniljekorn ved svag varme, (ca. 2 min.).
2
Skær de to appelsiner i meget tynde skiver. Fjern evt. kerner.
3
Kog appelsinskiverne i sukkerlagen ved svag varme uden låg, til de hvide hinder er glasklare, (ca. 1 time).
4
Læg skiverne i ét lag på et stykke bagepapir til afkøling, og gem sukkerlagen.
5
Hak ¼ af de karamelliserede appelsiner i mindre stykker.
6
Skær skrællen af de friske appelsiner med en kniv.
7
Skær fileter mellem hinderne, eller skær appelsinerne i skiver, og skær dem i mindre stykker. Fjern evt. kerner.
8
Pisk fløden til skum, og vend yoghurten i.
9
Læg en bund på et lagkagefad, fordel den friske appelsin over sammen med den hakkede karamelliserede, så yoghurt-flødeskummet og så en bund mere.
10
Pynt med karamelliserede appelsinskiver og lidt af sukker-lagen.
Fyldet
1,5 kg appelsiner
2,5 dl piskefløde
200 g græsk yoghurt
Marengsbunde
5 æggehvider
1 tsk. æbleeddike
250 g rørsukker
100 g mandler
Karamelliserede appelsiner
3 dl vand
300 g sukker
1 vaniljestang
2 usprøjtede appelsiner

Nyhed hos din lokale markilux forhandler
Få de smukkeste skyggeløsninger i verden. markilux designmarkiser er en innovativ løsning, hvor teknik og brugervenlighed er af højeste kvalitet. Markiserne er flere gange præmieret med udmærkelser af fagfolk. Gør din markise helt personlig: Vælg en løsning fra markiux.
Yderligere informationer finder du hos din lokale markilux forhandler og på markilux.dk




Pris pr. person i dobbeltværelse

Spar 50%

Bo i Frederikshavn og nyd nogle særdeles gode spiseoplevelser. Oplev den dejlige natur omkring byen og snup en smuttur til skønne Skagen. Pakken byder også på en fantastisk fiske- og skaldyrbuffet hos den kendte Jacobs Fiskerestaurant.
• 2 x overnatning + 2 x stor morgenbuffet
• 1/1 flaske vin på værelset
• Aftenmenu på ankomstdagen: Herman Bangs berømte steak med french fries, salat og sauce
• Frokost: Fiskebuffet på Jacobs Fiskerestaurant
• Fri kaffe under hele opholdet
Ankomst torsdag eller fredag. 50% rabat på værelsesopgradering. Tillæg i ugerne 27-31. Tilbudet gælder til 22/12-18. Bestillingskode: idefisk
Hotel Herman Bang
Tlf. 98 42 21 66 · hermanbang.dk
Pris pr. person i apartment. 4 dage.

1.349
Spar 136,-

Hold ferie i kurbyen Bad Lauterberg og bo på Aparthotel Panoramic, der bl.a. har swimmingpool, spa, dampbad og fitness. Nyd de storslåede naturskønne områder og den korte afstand til Harzens mange seværdigheder.
Opholdet inkluderer:
• 3 overnatninger m. morgenbuffet
• 3 x 3-retters aftenbuffet
• Gratis drikkevarer (17.30-21.00)
• Gratis parkering
• Adgang til pool og sauna
Ankomst indtil 23/12 2018. Sæsontillæg 100 kr.
Turistskat (person) pr. døgn 2,20 EUR.
Bestillingskode: læseride
Risskov Bilferie
Tlf. 70 22 77 17 · risskov-bilferie.dk




Bornholm, kontrasternes ø og hele Danmark i en nøddeskal - du tror det ikke før du har set det! Bo i store Luksushytter med stor terrasse med havudsigt. Alle udstyret i særklasse (nogle med spa) med al komfort du finder i et sommerhus.
Alt dette får I med:
● 2 personer i 1 uge
● Stor Luksushytte med havudsigt
● Færgen Ystad – Rønne t/r med bil
● 1 x Stor aftenbuffet for 2 personer i Gudhjem på Bornholms buffetrestaurant Brøddan Gælder ugerne 13 -18 samt i uge 37-41.
Rejsedage udenfor weekender og på udvalgte færgeafgange. Bestillingskode: Læsertilbud idényt 2018.
Tlf. 56 48 52 11 · sannesfamiliecamping.dk
Pris pr. person i delt dobb.vær.
1.695

Spar 50 %

Bo på den gamle hyggelige slægtsgård midt i den bakkede sønderjyske natur med skøn udsigt til Flensborg Fjord. Området byder på rige natur- og kulturoplevelser, ligesom en indkøbstur til Flensborg er oplagt – en køretur på kun 15 min.
Benniksgaard Hotel, Flensborg Fjord ****
• 3 x overnatning
• 3 x stor morgenbuffet
• 3 x 3-retters aftensmadmenu/buffet sammensat af køkkenchefen
Tillæg fredag og lørdag kr. 150,- pr. person pr. nat. Ankomst alle dage frem til 30. april 2018.
Ingen tillæg for enkeltværelse.
Bookingkode: idenyt3
Tlf. 74 65 09 49 · benniksgaardhotel.dk




Strømberg & Fischer Lysspejl med sensor til vægmontering –700x500 mm. strombergbad.com Værdi 3.200,-

Røgsuger til din skorsten – nem optænding af din brændeovn. draftbooster.dk


29. marts - 2. april 2018 kl. 12-16








Vil du køre land og rige rundt efter inspiration til det nye fritidshus, eller vil du køre til Middelfart?
Drømmer du om et moderne og funktionelt fritidshus? Et klassisk sommerhus, der dufter af træ? Eller et helt tredje? Uanset hvad, kan du med garanti nde et fritidshus, der matcher dine drømme i Danmarks største udstilling af fritidshuse.
Tag en tur til Middelfart og gå på opdagelse. Mærk stemningen, lyset, duften og kvaliteten af materialerne i de forskellige huse. Og nd ud af hvilket fritidshus, der bedst dækker din families behov.
Hindsgavl Allé 2 · 5500 Middelfart
T: +45 70 12 36 00 · www.huset-middelfart.dk



DANMARKS STØRSTE UDSTILLING AF FRITIDSHUSE
Det er ofte både en stor beslutning og investering at bygge drømme-sommerhuset. Det kræver råd, vejledning og inspiration.
I HUSET Middelfart kan du se og sammenligne hele 13 forskellige fritidshuse fra 6 forskellige leverandører.
Se mere på huset-middelfart.dk/fritidshuse


En carport fra Lyngsøe beskytter ikke bare bilen mod snavs, sne, regn og rusk, men giver dig samtidig et ekstra uderum til dig selv og bilen.
Vi giver dig 15 års garanti på en carport, der øger værdien af din bolig og gør dig glad hver gang du tager afsted - og igen når du kommer hjem.


Giv os et ring på 7196 9936
... vi vil så gerne tale med dig!









Vinduer og døre med palæsprosser og pæne farver.
Vinduer og døre udført med forskellige farver i i fuge. Når glas og fyldninger skal monteres tilbyder vi at udføre silikonelimen i sort, hvid, grå, brun eller klar silikone. Det vil fx sige at hvide fyldninger kan være limet i med hvid silikone. På den måde undgår vi sorte kanter langs glas og fyldninger





Vinduer og døre udført i træ/alu eller plast
Nemt at vedligeholde og kan fåes med højisolerende 3-lags lavenergiruder. Pæne afrundede profiler og vi tilbyder i flere vejrbestandige farver. Mange forskellige muligheder – forespørg på vores udvidede indbrudssikring.



Vinduer og døre med buer og udskæringer.


Vinduer og døre udført med buet overkam eller med udskæringer. Sætter ofte lige prikken over iét på huset og kan udføres i mange forskellige udgaver. Vinduer og døre med buet overkarm anvendes både i ældre huse og i nybyggeri.
Vinduespladsen tilbyder alle trappetyper fremstillet af træ, glas eller stål.
VIDSTE DU:
- At skridtlængden på din trappe er afgørende for hvor god din trappe er at gå på.
- At de fleste har fødder som kræver mindst 20 cm brede trin når man går på trappen





Vinduer og døre med diagonale sprosser og glasudskæringer.
Vinduer og døre kan udføres med diagonale krydssprosser, ovale vinduesudskæringer og diamantfyldninger. Vi tilbyder flere forskellige sprossetyper, fyldninger og kombinationer heraf. Det er vigtigt at vinduer og døre passer til husets udseende.
- At hvis man ændre en trappe fra at være en lige trappe til at dreje et kvart sving - så skal trappen være længere.
- At der bl.a. kan monteres lys i trin, børnesikringslister, skridsikkerhedslister, trinnæser og brandsikring på en trappe
- At trapper kan udføres med pladsbesparende trin hvis det kniber at trappen kan være der.
- At din trappe bl.a. kan udføres med bambus-, nødde-, elme- eller birketrin.
De fleste vælger at vi både skal opmåle, levere og montere trappen for at få en samlet løsning.










































Læs
Mal i høj fugt
Når du maler træværk indendøre, så er det en god idé at vente til en dag, hvor det regner udenfor. Malingen løber simpelthen pænere sammen, når du maler i høj luftfugtighed. Derfor skal du heller ikke begynde at lufte ud, før malingen er overfladetør. Så undgår du også at hvirvle for meget støv op, der kan sætte sig fast i det tørrende maling.
Brug lim på klinker
Det er ikke så nemt at bore huller i klinker. Boret glider nemt, du risikerer at bryde vådrumsmembranen, og den dag du vil flytte sæbeholderen, så efterlader det en hullet klinke, der ikke lige lader sig stoppe uden spor. Prøv i stedet at lime emnet op. Der findes flere slags lim, der er beregnet til montering i vådrum, og de holder forbavsende godt, og kan efterfølgende fjernes uden spor.

Skal du sætte nye ting op på væggen i badeværelset, så overvej at bruge lim i stedet for at bore hul i klinkerne.

Månedens tip
Mirakler med soda

Det tager ikke lang tid at få gammelt kobbertøj skinnende blankt.
Sodablæsning er en uhyre effektiv metode til at fjerne lak, maling og genstidig snavs fra metal, træ og endda plastik.
Og samtidig med, at det er effektivt er det også skånsomt, så du kan fx fjerne lak fra en bil uden at skulle dække gummilister og vinduer af.
Metoden blev opfundet, da Frihedgudinden skulle renoveres, og den store statue skulle renses uden at skade kobberpladerne, som den er lavet af.

Det er nemt at se inspirationen fra en kædesav i den nye hobbysav fra Bosch.

Snavs og gammelt lak fjernes let og skånsomt med en sodablæser.

Især bilentusiaster, der renoverer ældre biler helt ned til de mindste møtrikker, har fået øjnene op for soda. Soda blev tidligere brugt som et universelt rengøringsmiddel, før supermarkedernes hylder bugnede af duftende afarter af sæbe.
Men det har vist sig, at soda, der i tør form er et fint pulver, har en helt særlig evne, når det bliver blæst ved hjælp af en kompressor.
Du kan sagtens købe en sodablæsepistol til hobbybrug for omkring 500 - 700 kr.
Ny type sav Bosch har lanceret en helt ny type sav, der på en måde ligner en mellemting mellem en stiksav og en miniature kædesav. EasyCut 12 er navnet, og den bruger en ny teknologi, som Bosch kalder for NanoBlade. Der er ganske simpelt tale om en meget lille kæde, der fungerer som en rigtig kædesav, så man undgår de rystelser, som en stiksav forårsager. EasyCut 12 er en universalsav, der kan bruges både inde og ude, på værkstedet og i haven. Saven er let at håndtere med en vægt på bare 900 gram.
Isolerende spartelmasse
Skal du renovere en ydervæg indvendigt, så kan det være, at du skal prøve at tage et kig på Bostiks spartelmasse "Roll Thermo".
Det er nemlig den første isolerende spartelmasse i handlen, og ifølge Bostik kan den mindske varmetabet med op mod 15%, og dermed forbedre indeklimaet og reducere fornemmelsen af kolde vægge. Samtidig er den nem at påføre, da du bare skal bruge en rulle. Fås i 6,5 liters spande.

Væggen bliver spartlet og får lidt ekstra isolering i en arbejdsgang.

1
Tjek tag og tagrender efter vinteren
Vinteren kan være hård ved taget, og har du ikke tid til det store tagtjek lige nu, så tjek nogle af de ømmeste punkter. Tjek først i tagrenderne - ligger der her stykker af tagmateriale, så er det tegn på, at taget er ved at forvitre. Kig også efter revner i tagbelægningen, og tjek, at sten eller plader ikke har forskubbet sig i løbet af vinteren
2
Fugesand ml. fliser
Foråret banker for alvor på døren, og det sikreste forårstegn er som altid, at ukrudtet viser en fantastisk grokraft. Vil du sikre dig mod en uhæmmet
mængde ukrudt mellem fliserne, så er det nu du skal friske fugerne op med nyt fugesand. Begynd med at fjerne gammel ukrudt mellem fliserne og rens fugerne op. Gør evt. belægningen ren med vand og lad stenene tørre. Nu er det tid til at feje nyt fugesand ned i fugerne. Fej både diagonalt og lige på fugerne, så du arbejder mest muligt materiale ned mellem fliserne. Til sidst fejer du belægningen ren og glæder dig over, at du er foran ukrudtet mellem fliserne.
3
Haveredskaber klar
Fik du ikke gjort haveredskaberne helt rene og klare, da sæsonen sluttede, så er det nu, de skal gøres klar til en ny sæson. Plæneklipperen skal rengøres godt for gammelt græs, og kniven skal måske slibes. Diverse håndredskaber bør du også gøre rene, og spaden og øksen og andre redskaber, der skal være skarpe, bør også slibes. Har redskaberne træskafter, kan du slibe dem let med sandpapir og så give dem en omgang olie. Det pynter og forlænger skaftets liv.

Starter du sæsonen med at fylde nyt fugesand mellem fliserne, så minimerer du årets ukrudt.


At købe et nyt tag er en langsigtet investering. Det er derfor vigtigt at gøre sig de rette overvejelser om udseende, kvalitet og holdbarhed. Med et tag fra Profilmetal sikrer du dig et smukt tag i høj kvalitet.
Se mere på profilmetal.dk
Få nyt tag fra kun 372 kr. pr. mdr.
Vælg den tagløsning, der passer dig
Tagstensplade, 10 års garanti
Tagstensplade, 40 års garanti
100% genanvendelige materialer
Ekstra lyddæmpede tagplader
Træpakke 1*
Træpakke 2*
Komplet aluzink tagrende+nedløb
“Skjulte” skruer
Vedligeholdesesfri vindskeder i stål
Vindskeder i zink
Solceller, 4,76 kW anlæg
Regnvandstønde
Gør-det-selv startpakke
Pris incl. moms fra kr. 19.000 24.000
Pris pr mdr. fra kr. 372 Ring for pris
1* Træpakke m. lægter og skruer / 2* Træpakke m. lægter, vinskeder, stern & skruer
Priser er ved 110 kvm tag. Læs mere om vores grønne tagløsning på voresgrønnetag.dk
Lån op til 60.000 kr. Helt uden renter og gebyrer
*Lånet tilbydes I samarbejde med Resurs Bank. I beregningerne er det forudsat, at et givent lån er optaget den 15. i en given måned.


Nu kan du få kalkfrit vand i hele hjemmet, slippe for besværlig rengøring og nyde de mange fordele.
Mange husstande kæmper dagligt med kedelige belægninger fra kalken i vandet. Det medfører besvær og koster mange penge i energi og slid på installationer. Nu er det muligt at slippe af med kalken. Ved at installere et blødgøringsanlæg i huset fjernes kalken fra vandet, og det hårde vand bliver silkeblødt og kalkfrit.
Med kalkfrit vand slipper du for de kedelige kalkpletter på fliser, klinker, vandhaner og toilet. Rengøringen bliver nem og ubesværet. Vasketøjet bliver blødt og behageligt og bevarer farverne. Samtidig kan sæbeforbruget halveres, og skyllemiddel kan helt undværes.
Sådan virker anlægget


Anlægget skal tilsluttes af en VVS-installatør


BWT AQA basic
Blødgøringsanlægget leverer kalkfrit vand til den gennemsnitlige familie på op til fire personer. Godkendt til drikkevand.





Store besparelser
Selv små kalkbelægninger på varmelegemerne betyder, at der skal bruges mere energi. Med kalkfrit vand spares der el på bl.a. elkedlen, vaskemaskinen og varmtvandsbeholderen. Der er også store besparelser på rengørings- og afkalkningsmidler til stor gavn for miljøet.
Test dit vand for kalk
Bestil en gratis brochure med teststrip på
www.kalkfrit-vand.nu




BWT AQA life
Et blødgøringsanlæg, der leverer kalkfrit vand til den store familie med et større vandforbrug. Godkendt til drikkevand.
Kalkfrit badeværelse
Rengøring af vandhane, toilet og håndvask klares med en blød klud.
Undgå afkalkning
Ingen afkalkning af f.eks. kaffemaskine og elkedel
Spar energi og penge
Undgå kalk på varmelegemer i vaskemaskine og varmtvandsbeholder.
Blødt hår og blød hud Hud og hår, der ikke udsættes for kalk fra vandet, tørrer ikke så nemt ud.
Blødt og pænere tøj Uden kalk i vandet bevarer tøjet og håndklæderne deres blødhed og farver.
Godt for miljøet Med kalkfrit vand kan du halvere dit forbrug af sæbe og rengøringsmidler.
Følg BWT Danmark på Facebook og få gode råd til at fjerne kalken.


Bestil et tilbud
Bestil et gratis og uforpligtende tilbud ved at skanne koden eller på

BESTSELLER
Dansktalende
vært

679,333,- Fra kun

KØTILBUD:
Maks 1. vær. pr. booking Altid et godt rejsetilbud - mere end 700
Kun 20 km. fra grænsen og Flensburg
Landgasthof Tarp



Besøg
Voergård Slot!
Spar op til
499,596,- Fra kun
• 2 x 3-retters menu
• 2 x kaffe og kage
• 1 fl. vin pr. vær. ved afrejse
• 1 spillerunde på keglebane
Vestjylland, Videbæk
Hotel Falken
• 2 x overnatninger
• 2 x morgenbuffet
• 2 x 2-retters menu/buffet
• Gratis internet
• Gratis parkering

• 2 overnatninger m. morgenbuffet



Inkl. gratis drikkevarer til middagen





Schleswig-Holstein,
Hotel Plöner
Spar op til


Dronninglund Hotel
679,956,- Fra kun
• 3 overnatninger m. morgenbuffet
• 3 x 3-retters menu/buffet
• 3 x kaffe og småkager
• 3 x før middag drink
• Inklusiv miljøtillæg


Tag på smuttur til Aarhus!




749,-
Hørning Kro og Hotel
• 2 overnatninger
• 2 x morgenbuffet

• 2 overnatninger
• 2 x 2-retters menu/buffet
• 1 x kaffe og kage
• Gratis internet og parkering

• 2 x morgenbuffet
• 2 x 3-retters
• 1 x velkomstdrink
Spar op til

SÆRTILBUD marts-maj! 956,-
• Gratis internet

1199,286,-
Vi

Husk bestillingskoden: risskov-bilferie.dk
• Gratis drikkevarer (17:30-21:00)
Ring og hør
Forbehold for
• Adgang til wellness "Pano Beach"
• Prisen er pr. fra kr. 79,-



Så billigt, at du ikke har råd til at blive hjemme


Inkl. gratis drikkevarer til middagen



Schleswig-Holstein, Damp
Ostsee Resort Damp
• 2 overnatninger m. morgenbuffet
• 2 x 3-retters menu/buffet
• Gratis drikkevarer til hver middag
• Adgang til Fun & Sport Center
• Adgang til sauna og saltvandspool

SÆRTILBUD marts-maj!






Schleswig-Holstein, Plön
Hotel Plöner See by Tulip Inn



• 2 overnatninger

• 2 x morgenbuffet
• 2 x 3-retters menu/buffet
• 1 x velkomstdrink
• Gratis internet

Spar op til
(17:30-21:00) "Pano Beach" morgenbuffet afrejse keglebane




Schleswig-Holstein, Ahrensburg
Hotel am Schloss Ahrensburg
• 2 overnatninger
• 2 x morgenbuffet
• 2 x 3-retters menu/buffet
• 1 velkomstdrink
• Gratis internet
Vi har gode tilbud på WEEKENDOPHOLD, MINIFERIE og SOMMERFERIE, så tag et kig på Risskov Bilferies nye hjemmeside!
Inklusive 5-retters menu!

Sønderjylland, Rødekro
Røde-Kro
• 2 overnatninger m. morgenbuffet


• 1 x 2-retters menu
• 1 x 5-retters menu
• 1 velkomstdrink
• Kaffe og sødt efter middagen


Husk bestillingskoden: IDÉNYT risskov-bilferie.dk 70 22 77 17
Ring og hør nærmere i hverdage 9-17 lør. og søn. 10-15
Forbehold for udsolgte datoer og trykfejl • Rejsearrangør: Risskov Autoferien AG
• Prisen er pr. person i dbl. vær. • Minimum inkl. slutrengøring • Ekspeditionsgebyr fra kr. 79,- • Spar ift. hotellets egen pris






TILSKUDSPULJE ER ÅBEN!
Typisk 10.000 - 20.000 kr i nettotilskud
I 2018 kan du både søge tilskud*) og benytte håndværkerfradrag samt sælge dit overskudsstrøm. Se hvor meget tilskud du kan få på: vivaenergi.dk/tilskud





Hvad koster solceller?

Hybrid solcelleanlæg med batterilager



Pakkepriser fra kr. 17.400,- f.eks.:
3 kWp anlæg kr. 37.725,-
Producerer 2700-3000 kWh om året.
4,3 kWp anlæg kr. 53.100,-
Producerer 4200-4300 kWh om året.
4,3 kWp Hybridanlæg kr. 73.900,Producerer 4200-4300 kWh om året, 9.6kWh batterilager.
6 kWp Hybridanlæg kr. 88.750,Producerer 5500-5600 kWh om året, 9.6kWh batterilager.
Priserne gælder for komplette materialepakker med tagmonteringsystem til eternit, betontagsten eller stålplader. Eventuelt tilskud er ikke fratrukket.


Vi leverer både almindelig og hybrid solcelleanlæg, hvor hybridanlægget har nogle ekstra fordele:
• Vores hybridanlæg gemmer solenergien til natten og reducerer dit elkøb.
• Du får op til 60% bedre totaløkonomi i forhold til et alm. solcelleanlæg.
• Bliv næsten selvforsynende med din egen grønne strøm i sommerhalvåret.




Vi har de sidste 7 år leveret over 2200 solcelleanlæg, samt over 1800 batterianlæg. Læs her hvorfor vi blev valgt som leverandør: vivaenergi.dk/omviva

Elbesparelse 1. år *): 6.774,-
Elbesparelse total (30 år): 300-350.000,-
Afkast hvert år (GDS/Mont.): 10% / 8%
Egetforbrug af grøn solproduktion: 73%
Salgsværdi af overskudsstrøm 10-20.000 kr
(Læs mere på vivaenergi.dk/elsalg)

Solceller er den bedste energiinvestering idag, og giver et flot afkast af dine penge.
Til venstre ser du den typiske elbesparelse for en gennemsnitsbolig. Besparelse / indtjening er skattefri!








Beregningen gælder for et 4,3kWp hybridanlæg til 73.900 kr for Gør-Det-Selv anlæg, og 95.400 med standardmontering (kan afvige). Til en bolig med et årsforbrug på 6000kWh og dagsforbrug. Sydvendt tag med 25-35º hældning. Tilskud er ikke fratrukket.
*) Tilskuddet beregnes som 60 øre pr. solgt kWh de første 5 år, plus ekstra tilskud til lithiumbatteri og sorte design-paneler. Tilskudsdelen udbetales umiddelbart efter etablering af anlægget. Bemærk at 6KW grænsen er væk. Viva Energilån
Vi beregner gerne økonomien for dit anlæg. Se boksen herunder og bestil et solcelletjek.














Drømmer du om en bugnende grøntsagshøst, skal du starte en del af grøntsagerne i vindueskarmen.

TRÆNGSEL i spirebakkerne betyder, at du må i gang med at tynde ud.

Din vindueskarm er en GRØN ven, når det handler om grøntsager. Her starter du årets køkkenhave.
Marts og april er højsæson for forspiring af grøntsager til køkkenhaven under lune, beskyttede forhold i vindueskarmen.
En række af de mest populære grøntsager i køkkenhaven er temmelig varmekrævende, og det betyder, at de ikke kan sås direkte i jorden før allersidst i maj. Dermed har de travlt, hvis de skal nå at spire, vokse til og give et godt udbytte, før sommeren er forbi.
Derfor er det smart at give de varmekrævende grøntsager et forspring ved at forspire dem inden døre og plante dem ud, når risikoen for frost er helt ovre – sidst i maj. Så er de allerede godt i gang og kan nå at blive til en hel masse i løbet af sæsonen.
Timing er vigtig
Nu gælder det ikke om at komme i gang så tidligt som muligt. Vindueskarmen er lun og be-
skyttende, men lysforholdene inde er ikke ret gode, med mindre man ligefrem investerer i vækstlys til de små.
En lun vindueskarm med ringe lysforhold resulterer i lange, ranglede planter, der sjældent bliver til gode grøntsager, når de plantes ud. De må kæmpe med barndommens mistrivsel hele deres liv. Derfor gælder det om at time sin forspiring, så planterne tilbringer den nødvendige tid i vindueskarmen men heller ikke mere.
Grøntsager, der ikke er kuldskære, kan med fordel sås direkte i køkkenhaven. Så sparer de en omplantning eller to, der alt andet lige kan bremse de spæde planter.
Lyst og køligt
De fleste grøntsager spirer fint ved stuetemperatur. Salat er en undtagelse, for salatfrø spirer dårligt ved temperaturer over 20°. Så find et køligere sted
til salaten. Efter fremspiring er det under alle omstændigheder bedst at reservere en kølig men solbeskinnet vindueskarm til bakker og potter med småplanter, så planterne bliver stærke og harmoniske.
Husk at tynde ud
Når du sår, gælder det om at så tyndt, så der ikke er for mange frø i bakken. Det giver bare mere arbejde, når de spirer frem, for småplanter, der står som sild i en tønde, bliver ikke til gode udplantningsplanter.
Tynd under alle omstændigheder ud, så der er god afstand mellem planterne. Brug fingrene eller en pincet til at trække de overskydende planter op og vand efterfølgende, så jorden falder godt til om de tilbageværende planter.
Står planterne med god afstand i bakken – og har du timet forspiringen godt – kan de plantes direkte ud i haven sidst
i maj. Bliver de så store, at de må kæmpe om pladsen i bakken, er det nødvendigt at plante dem om en ekstra gang, så de får hver deres potte at brede sig i.
Planter, der starter deres liv i vindueskarmen, har levet en beskyttet tilværelse, så forholdene i køkkenhaven med direkte sollys og vind, kan være en barsk oplevelse.
Derfor er det bedst at afhærde planterne før udplantning, ved at stille dem udenfor midt på dagen i mildt vejr og tage dem ind igen ved aftenstide. Efter nogle dage kan de stå på et beskyttet sted i et par uger, før du planter dem i deres endelige voksested.
Lad dig ikke lokke af forårssolen men plant ud på en gråvejrsdag, det er mest skånsomt for planterne.
Tekst og fotos: Lotte Bjarke
Artiskok
Kål
Porre
Knoldfennikel
Hovedsalat
Raddichio
Endivie

NÅR DU SÅR grøntsager i bakker, betaler det sig at sørge for, at der er god afstand mellem frøene. Husk, at de alle sammen kan blive til en lille plante, der kræver plads omkring sig.

Pluksalat
Radise
Rucola
Spinat
Gulerod
Ært
Rødbede
Kronborgs vinkælder udtørret – se reference på h2oblock.dk

Squash
Græskar
Bønne
Majs
Drueagurk
KULDE, NÅR FRØENE SPIRER, kan betyde, at fx kål og porrer går i stok og blomstrer. Derfor er vindueskarmen en god start på livet for de varmekrævende grøntsagsarter.

SÅ
STORE, at de må slås om pladsen, så plant dem om til individuelle potter, så de har plads at udvikle sig på.



Drømmer du om en tør kælder?
Få fuld udnyttelse af din kælder efter installation af en H2OBlock
SKIL planterne forsigtigt fra hinanden, så alle har roden i behold, når du planter ud.



Få et gratis fugttjek, ring på 49760110
Brochure og rådgivning fås på 49760110 eller på post@h2oblock.dk samt på www.h2oblock.dk/ide



Drømmer du om en tør kælder med et sundt indeklima så er den enkle løsning en H2OBlock fra Faxe Design. Lugtgener forsvinder i løbet af et par uger og kælderen bliver permanent udtørret. H2OBlock systemet er et trådløst system som installeres uden gravearbejde og indgreb i murværk.
H2OBlock fjerner opstigende fugt og beskytter ejendommen ved hjælp af det, der kaldes elektro-osmose. Den udtørrer mere end 300 m2 selv om der er tale om flere rum. Den fjerner fugt i inder- og ydervægge samt i gulve og en H2OBlock forhindrer dannelsen af skimmelsvamp. En H2OBlock er væsentlig billigere end omfangsdræn og andre kendte løsninger.
Pris 34.900,00 kr. Inkl. moms og montage
Returret samt 10 års funktionsgaranti





Kan leveres som EU 45 og 25 km invalideknallert, som kan køres uden kørekort. Unik smidighed og lasteevne. Stærk 50cc benzinmotor og lang rækkevidde. Bestil brochure. Kørekortfri “bil” TMP • Tlf. 97 74 07 33 • www.tmp.dk

Gratis prøvepakke
Skal du lægge nyt termotag på udestuen, carporten el. orangeriet, så bestil en gratis prøvepakke med rabatkode DP181, og få et godt tilbud fra os – info@deigaardplast.dk
Tlf. 86 24 66 00 www.deigaardplast.dk



Så kontakt Uretek. Vi stabiliserer og løfter fundamenter og gulve uden opgravning og fraflytning. Din løsning uden gener! Revner og synker dit fundament eller gulv?
Tlf. 70 20 33 01 · www.uretek.dk



Brug for ekstra plads?
Med Flexanex kan man designe sit eget redskabsrum, hobbyværksted, kolonihavehus, anneks. Du bestemmer selv hvor døre og vinduer skal være.
www.FLEXANEX.dk • Tlf. 9625 3022

Stort udvalg af træpavilloner. Type Ærø med dobb. dør og 4 dobb. vinduer. Kampagne kr. 18.840 incl. levering. Tagshingels kr. 1.960. Rabatkode Y181. Pavilloner med thermoglas www.pavillongruppen.dk - tlf. 2020 2899


Husmår væk www.resenborghus.dk • Tlf. 22 40 61 17
Lyde og lugte, ødelagt isolering/bid i elinstallationer kan betyde, at husmåren er flyttet ind i din bolig. Bliv husmåren kvit, kontakt Resenborghus. Faglig & kompetent rådgivning.


Scan og bestil et gratis fugttjek Bestil et uforpligtende fugttjek på drytech.dk
Nyhed: Tag kampen mod svampen
Drytech løser problemer med opstigende grundfugt i kælderen med en lille elektrisk installation i kældervæggen. Drytechs system er vedligeholdelsesfrit. Tlf. 70 10 80 11.
Skimmelsvamp ligger altid og lurer, og det er utrolig sundhedsskadeligt at bo i. Derfor skal du bekæmpe den med det samme. Med den nye Rodalon Skimmel PLUS kan du nemt fjerne og dræbe skimmelsvamp og også slå svampesporerne ihjel.
Bare spray på og lad Rodalon Skimmel PLUS klare arbejdet.
Få info på borupkemi.dk · Tlf. 57 56 00 20 · Facebook: Gør det selv - bedre
Hvilken robotstøvsuger er bedst? Hvilken smart sundhedsgadget? idényts læsere har stemt – og vinderne i de 16 smarthome-kategorier er fundet. Læs meget mere om vinderne på smarthomelaeserprisen.dk




ROBOTSTØVSUGER
IROBOT, ROOMBA 980, 8.499 KR.
Roomba-støvsugeren kan klare en bolig på 186 m2 og kan uden problemer klare forhindringer takket være de indbyggede kameraer. Styres med en app.
ROBOTPLÆNEKLIPPER
HUSQVARNA, AUTOMOWER
430X, 21.995 KR.
God til udfordrende og ujævnt terræn, fordi den kan klare høje stigninger. Er også velegnet til større haver.
RENGØRING
VORWERK, KOBOLD VT 300
9.995 KR.




KØKKEN
... hvor du også kan deltage i KONKURRENCEN om to smarthomepakker til en værdi af 15.000 kr. pr. stk.
DE DIETRICH, MULTIFUNKTION PLUS OVN MED PYROLYSE, 15.999 KR.
En ovn, der har pyrolyse, så den kan rense sig selv. Den har indbyggede opskrifter, så madlavningen bliver nemmere. Ovnen har også et display, hvor man kan indstille specielle funktioner.
GARDENA, SMART SYSTEM-SÆT
19.199,95 KR.







Kombineret støvsuger og gulvvasker, der dog ikke er automatisk. Indbygget automatisk gulvsensor, som tilpasser mundstykkets udformning og sugestyrke.
SIKKERHED
NETAMO, WELCOME, 1.599 KR. Et indendørs overvågningskamera, der har ansigtsgenkendelse. Giver besked på din telefon om, hvem der er kommet hjem, og alarmerer dig, hvis en ikkegenkendelig person træder ind ad døren.



Gardena er smart, fordi dette system automatisk slår dit græs, vander din plæne og overvåge jordens fugtighed.
SUNDHED




TANITA RD 953
KROPSANALYSEVÆGT, 2.499 KR.
En vægt, der kan analysere kroppens fedtindhold, muskelmasse, knoglemasse, BMI mm. 4 forskellige brugerprofiler til 4 familiemedlemmer.
LYSPÆRER
PHILIPS, HUE COLOR E27

STARTERKIT, 1.490 KR.


LED-pære, der kan skifte farve og styres gennem en app. Philips var de første på markedet med smarte pærer og har dermed stor erfaring, et bredt sortiment og et stort community af brugere.






DELONGHI, PRIMADONNA ELITE
EXPERIENCE ECAM, 16.199 KR.
Semi-automatisk kaffemaskine med 6 brugerprofiler til hele familien. Kan styres gennem app og har automatisk rengøring.

HJEMMEUNDERHOLDNING
LG, OLED SMART UHD TV
28.999 KR.
Smart-tv, der bruger den nye OLEDteknologi, som giver et skarpere og bedre billede. Direkte understøttelse af Netflix.


PHILIPS, HUE MOTION SENSOR, 299 KR.



Batteridreven sensor, der opfanger bevægelse og lys og tænder og slukker lyset automatisk. Nem at sætte op. Fungerer kun med Philips Hue-system.





TECFLOWER, ANDI BE TRÅDLØS
BORDOPLADER, 822 KR.


Opladeren lader din mobil trådløst eksempelvis på dit skrivebord, men kan også anvendes, hvis dit barn skal spille eller se film på din Iphone eller Samsung-smartphone.
LINKSYS, VELOP, 3.949 KR.
Med de tre enheder fra Linksys er du sikret fuldstændig dækning – selv i det store flerplanshus.
DYSON, PURE HOT + COOL LINK, 4.499 KR.

Dyson måler og renser luften i dit hjem. Har køle- og varmefunktion og er helt lydløs. Tilhørende app med målingsresultater.


PHILIPS, HUE GO, 599 KR. Transportabel, batteridrevet lampe. Formet som en halvkugle. Kan skifte farve og intensitet. Fungerer sammen med Philips Hue-system og kan styres gennem en app, når den er koblet til systemet.
HBUTLER, ORBIT, 231 KR.
Nøglering, der kan forbindes til din mobiltelefon. Hvis du har mistet din mobil eller dine nøgler, kan du trykke på en knap, som udløser en lyd, der hjælper dig med at finde dem. Kan også spores gennem en app.
FORÅR· er det – både ude og inde – vi inspirerer dig til spændende projekter

Jordbær med fløde – fra egen have. Det bliver ikke bedre. Vi har opskriften, der giver dig flere bær og mulighed for at høste længere.
Du kan både passe din have på den nemmeste måde og passe på miljøet. Producenterne er dygtige til at udvikle havemaskinerne, så de opfylder villaejernes krav. Vi viser dig årets super-maskiner.
Næste udgave omdeles 10. & 11. april

AEG · aeg-powertools.eu
Allux/Juliana · Tlf. 66 11 18 11
Bosch · bosch.dk· Tlf. 44 89 84 10
Dansk Stål Design · Tlf. 22 41 96 39
Ecostyle · ecostyle.dk · Tlf. 70 22 70 67
Gasa Young Plants · Tlf. 6010 5122
Garant Tæpper · garant.com· Tlf. 40 90 60 00
Jydsk Vindueskompagni · Tlf. 70 10 90 99
Kuhn Rikon/kuhnrikon.co.uk
Kitchen Aid · kitchenaid.dk/Kundeservice
Lotus Heating Systems A/S · Jens Hellsteninfo@lotusstoves.com · Tlf. 63 23 70 70
Luxaflex.dk
Lyngsøe · lyngsoes.dk· Tlf. 70 20 61 41
Mallingliving · malling-living.dk
MARKSLÖJD · markslojd.com
Massimo Copenhagen massimo.dk · Tlf. 48 42 25 73

Værdi 5.499,Witt




Energimærket på dit hus er en væsentlig brik, når du skal købe eller sælge en bolig. Det betaler sig at kende til både mærket og attesten – så læs med og bliv klogere.
En håndfuld friske LÆSERIDEER
Ideer til bekæmpelse af dræbersnegle
Byg et hyggerum i haven


Vakuumblender. witt.zone/witt/ vakuumblender-v1000-dk Auktionerne begynder mandag den 12. marts kl. 00.01 og slutter mandag den 26. marts kl. 19.30.


Metabo · metabo-service.com/da/
Normies/Norman normann-copenhagen.com
Odsif · odsif.dk · Tlf. 45 81 22 11
Orthex Group · orthexgroup.Dk
Rosti Mepal · rosti-mepal.dk
F&h· Tlf. 8928 1300
Staub · staub.com · Tlf. 3314 1405
Stanley · stanleyworks.dk· Tlf. 70 20 15 10
Stihl · stihl.dk
Tom Dixon/completliving.dk Velfac · velfac.dk · Tlf. 76 28 85 25
WOCA Denmark A/S wocadanmark.com · Tlf. 99 58 56 00
Zwilling · zwilling.com · Tlf. 3314 1405
Skimmel kommer altid når der er fugt. Løs dit fugtproblem, så kommer der ikke skimmel!
Skimmel forsvinder ikke af sig selv igen. Man skal gøre en indsats for at fjerne det.

Når der kommer skimmel i boligen, så er det altid på ”problemstederne”:



Fugerne i badeværelset
Den kolde ydervæg i soveværelset og bag på møbler der står op af denne væg
Vindueslysningerne


Når der er kommet skimmel, hva’ gør jeg så?
Skimmel fjernes med Protox Hysan. Er der behov for at forebygge ny skimmelvækst, efterbehandles med Protox Skimmel.
Find mere information og forhandlerliste på protox.dk
Fabriksvej 19 · 6000 Kolding Tlf +45 75 50 40 22 · info@protox.dk www.protox.dk





















